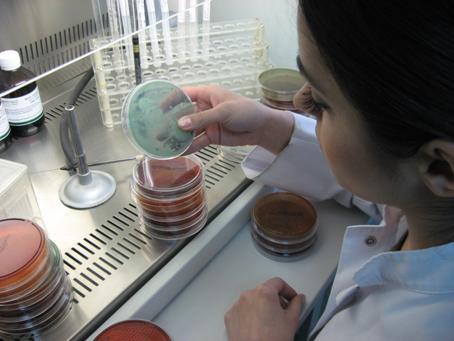

| CATEGORII DOCUMENTE |
| Alimentatie nutritie | Asistenta sociala | Cosmetica frumusete | Logopedie | Retete culinare | Sport |
MEDICINA VETERINARA
CONTROLUL SI EXPERTIZA PRODUSELOR ALIMENTARE
Evaluarea calitatii unor loturi de oua pentru consum comercializate in pietele bucurestene
INTRODUCERE
Nevoile mereu crescande ale populatiei, privind consumul oualor, constituie probleme majore ale autoritatilor sanitar veterinare, in scopul apararii sanatatii si asigurarii unor produse salubre.
Desi ouale sunt in general echilibrate si bine reprezentate in minerale, vitamine, proteine etc. ele pot reprezenta un pericol pentru om, in cazul unor alterari in timp cu ocazia depozitarii, transportului si comercializarii.
De aici rezulta necesitatea elaborarii unor norme privitoare la calitatea oualor de consum si supunerea acestora unor controale specifice prin care sa se releve calitatea acestora.
In acest context se urmaresc :
* Prevenirea imbolavirii consumatorilor datorita consumului de oua necorespunzatoare din punct de vedere igienic;
* Verificarea conditiilor de pastrare a oualor sub raport igienic si economic, in unitatile de crestere, de prelucrare si desfacere;
* Monitorizarea unitatilor de procesare si desfacere de oua in ce priveste respectarea normelor legale;
Cerintele imediate ale societatii moderne impun perfectionarea activitatii specialistilor care contribuie la apararea sanatatii animalelor si omului.
In acelasi timp cresterea consumului de oua pe plan international face imperios necesara perfectionare continua a pregatirii profesionale si inbunatatirea supravegherii sanitatii veterinare a productiei, circulatiei si valorificarii oualor.
PARTEA I - STUDIU BIBLIOGRAFIC
CAPITOLUL I
FORMAREA OULUI - LA PASARI
Aparatul genital femel este format din ovar si oviduct, organe pereche in stadiul embrionar, totusi cu dezvoltare mai pronuntata a ovarului si oviductului stang. In perioada postembrionara, ovarul si oviductul drept involueaza, astfel ca la pasarea adulta, numai ovarul si oviductul stang sunt functionale.
Ovarul se prezinta sub forma unui ciorchine, cu oviducte in diferite stadii de dezvoltare, din care se formeaza ovulele, respectiv galbenusurile oualor, dupa o perioada de acumulare de vitelus nutritiv de cca 14 zile. Desi ovarul puicutelor contine la doua zile dupa ecloziune pana la 3 milioane oviducte primare, ovarul gainilor adulte mai contine doar cca 2000 oviducte, din care doar o treime se maturizeaza, astfel incat o gaina nu poate produce decat cateva sute de oua.
Procesul de desprindere a ovulei maturate de pe suprafata ovarului, prin ruperea membranei vasculare se numeste ovulatie. Luind drumul oviductului, in segmentele sale, ovula sufera diferite transformari. In trompa are loc fecundarea, in camera albuminigena invelirea galbenusului in mari cantitati de albus, in istm se mai depune albusul si se constituie cele doua membrane cochiliere. In uter (camera cochilifera) se formeaza coaja minerala a oului, dupa care oul complet constituit trece in vagin, de unde este expulzat.
La pasari, celula sexuala femela matura (sau ovulul) este reprezentat numai de galbenus. Nucleul ovulei este situat la polul animal al galbenusului, fiind inconjurat de o cantitate redusa de citoplasma activa (sau vitelus formativ) impreuna cu care alcatuieste o formatiune discoidala, denumita disc sau pata germinativa. Restul ovoplasmei este format din vitelus alb (ce contine granule mici, cu compozitie predominant proteica - 43%) si din vitelus galben, ce cuprinde granule mari, formate in principal din lipide si proteine, in cantitate mai redusa (28 %).
Depunerea vitelusului incepe de sub discul germinativ, cu un strat de vitelus alb care se prelungeste spre centrul oului cu o formatiune cu aspect de limba de clopot, denumita latebra Purkinjie.
In afara acestui vitelus alb se dispune un strat de vitelus galben, iar in continuare are loc o dispunere a celor doua tipuri de vitelus in straturi concentrice alternative. La
periferie oul este invelit de o membrana vitelina (de ovolema).Fecundarea oualor are loc la nivelul ovarului sau in portiunea initiala a oviductului, inainte de a fi acoperit de albus, membrane cochiliere si cochilie.
Ovulul (vitelusul sau 'galbenusul') eliberat de pe ovar este captat de infundibulum. Dupa strabaterea portiunii tubulare proximale a infundibulumului, ovulul ajunge in 'regiunea salaziera' a acestui segment. In infundibul, ovulul este acoperit de un strat de secretii si incepe formarea salazelor.
Din infundibul, ovulul este trecut in magnum unde este acoperit cu secretii ce constituie albumenul ('albusul'). La patrunderea in istm are circa 50 % din masa sa finala. Din istm, ovulul acoperit de albumen patrunde in uter. In primele ore de stationare in uter, glandele uterine produc un fluid apos care patrunde in masa oului, determinand dedublarea acestuia. Urmeaza apoi procesul de formare a membranelor cochiliere interna si externa si apoi a cojii calcaroase. In timpul parcurgerii uterului, rotatia oului in jurul axei sale polare, definitiveaza formarea salazelor (inceputa in infundibulum) si stratificarea albumenului. Formarea cojii calcaroase are loc la o rata de mineralizare de 300 mg. calciu per ora. Calciul pentru coaja este preluat din sange. Tot uterul formeaza cuticula si pigmenteaza suprafata oului. Pigmentii sunt reprezentati de profirine.
In cursul formarii, oul ramane
timp de circa 15 minute in infundibulum. In magnum, el inainteaza cu o
viteza de cca
|
Segment al oviductului |
Perioada medie a transformarii oului |
Lungimea in cm |
Functia |
|
Palnia oviductului |
20 minute |
Preluarea ovulului si eventuala fecundare |
|
|
Segmentul principal al oviductului |
2-3 ore |
Formarea in straturi al albusului |
|
|
Ingustarea oviductului |
1,5 ore |
Formarea membranei oului |
|
|
Uter |
20-21 ore |
|
Formarea cojii calcaroase a oului |
Tabel nr. 1- Stadiile de formare a oului
In figura nr. 1 este aratat drumul pe care il parcurge oul inainte de a cadea in cuibar:

Figura nr. 1 - Stadiile de formare a oului, folicul ovarian - pontare
CAPITOLUL II
IMPORTANTA TROFICO - BIOLOGICA A OUALOR
Oul face parte din grupa de alimente III, astfel sunt alimente cu cea mai mare valoare biologica (valoare biologica = % de azot absorbit si retinut de organism). Continutul sau bogat in lipide complexe il face necesar consumului zilnic. Este o sursa importanta de vit. A, D, E, B2, B6, acid pantotenic si cele mai importante: Fe si P. Are o digestibilitate usoara.
Dezavantajele oului:
- contine mult cholesterol
- are actiune acidifianta
- sarac in vitamina C
In alimentatie, oul trebuie sa alterneze cu pestele si carnea. Contine proteine de gradul I cu un numar mare de aminoacizi esentiali in structura moleculara (de aceea, din punct de vedere biologic proteinele din ou au valoare 100, considerate etalon pentru celelalte tipuri de proteine). Contine lipide cu valoare biologica ridicata: a) colina - care elibereaza schimburile dintre lipide si glucide si previne hepatosteatoza; b) lecitina - favorizeaza schimburile trofice nervoase, lipide simple cu grad inalt de digestibilitate.
Este bogat in saruri
minerale: a) calciu - se gaseste in proportie de 60 mg la
Datorita concentrarii substantelor nutritive, digestia oului necesita o rata mare de secretii gastrice (mai mare decat necesarul secretor pentru carne sau lapte).
Pe langa favorizarea hiper-secretiei gastrice, oul mai reprezinta o serie de inconveniente: albusul crud contine o anti-triptaza ce blocheaza triptaza pancratica, mai contine si anti-biotina, ablele se inactiveaza prin tratare termica, poate determina soc
anafilactic la persoanele cu diferite leziuni ale tubului digestiv (atunci cand este consumat crud sau insuficient tratat termic.)
Compozitia complexa si repartizarea neuniforma a elementelor chimice fac ca partile comestibile al oului sa fie deosebit de instabile, fiind supuse din momentul producerii, la modificari continue.
La aceasta instabilitate chimica a galbenusului si albusului contribuie si faptul ca ele nu sunt complet izolate de mediu extern si prin porii cojii se gasesc permanent sub influenta lui.
De aceea este necesar sa fie supuse periodic unui examen sanitar - veterinar.
Standardele Uniunii Europene, au stabilit prin Ordonanta UE, nr. 1511/1996 ca, de la 1 August 1996, ouale nu mai sunt clasificate dupa clasele de greutate de la 1 la 7, ci dupa marimile XL, L, M si S, ca la imbracaminte, astfel sunt redate in tabelul nr . 2 :
|
Clasificare UE |
Semnificatie |
Clasa de greutate |
|
XL |
Foarte mare |
|
|
L |
Mare |
63 g- |
|
M |
Mediu |
53 g- |
|
S |
Mic |
Sub |
Tabel nr. 2- Standard de clasificare a oualor UE conf. Ord. 1511/1996
CAPITOLUL III
CARACTERIZAREA MORFOSTRUCTURALA,
FIZICO-CHIMICA SI MICROBIOLOGICA A OUALOR
3.1. CARACTERIZAREA MORFOSTRUCTURALA
Oul are forma ovala, caracteristica, prezentand un pol rotund si unul ascutit. Oul fecund constituie un zigot, care in conditii corespunzatoare parcurge fazele procesului de embriogeneza.
Oul constituie o rezerva insemnata de substante nutritive superioare, acoperite de o serie de membrane protectoare (cochiliere, coaja, cuticula), conditii indispensabile pentru dezvoltarea embrionului in afara organismului matern.
Componentele oului sunt diferite structural si chimic:
- Galbenusul (masa centrala de vitelus)
- Albusul (albumenul)
- Membranele
- Camera de aer
- Coaja si cuticula
3.1.1 GALBENUSUL
Este o uriasa
celula sferica, ovule fecundate sau nefecundate. Contine discul germinativ,
care este format din nucleu si citoplasma ovulara
(vitelusul formativ), atat la oul fecundat cat si la cel nefecundat.
Vitelusul nutritiv este dispus in straturi concentrice de vitelus alb
si galben. Vitelusul alb, constituie sub discul germinativ o
formatiune ca o linie de clopot, numita Latebra. Integritatea
galbenusului este mentinuta de membrana vitelina. Masa
centrala de vitelus reprezinta aproximativ ⅓
din masa oului si este echivalenta cu ovulul de mamifer. La
exterior, ovulul este acoperit de membrana perivitelina. O mica
formatiune din masa sa citoplasmica este reprezentata de
blastodisc (sau blastoderm, daca oul este fecund), sub forma unui spot
gri-albicios cu un diametru de
Discul germinativ pluteste intr-un con de vitelus albicios care se prelungeste spre profunzimea vitelusului, terminandu-se cu latebra.
Compozitia chimica a vitelusului albicios difera de cea a restului vitelusului. Rolul vitelusului este de a asigura materialul pentru embriogeneza. Din punct de vedere chimic vitelusul este o masa heterogena de proteine, lipide, pigmenti si susbstante anorganice. Lipidele se afla sub forma emulsionata.
Galbenusul are un continut mai scazut in apa, 46-54 % si o cantitate mai mare de proteine, 16-17 %.
Proteinele din galbenus sunt reprezentate in proportie de 78 % de ovovitelina, care reprezinta forma de depozit nutritiv a embrionului, liventina si globuline (proteine de transfer).
Galbenusul este bogat in trigloceride (aprox. 67 % din total) si lipide complexe (33 % din totalul lipidelor galbenusului, reprezentate de lecitine, cefaline, colina si steride de tipul colesterolilor), aceste lipide din galbenus reprezinta 36 % din masa totala.
3.1.2. ALBUSUL (Albumenul)
Albusul este dispus in jurul galbenusului formand patru straturi concentrice:
- primul strat de albus dens, strat subtire in contact direct cu galbenusul, din care se diferentiaza salazele, spiralele cu rol de a mentine galbenusul in centrul oului.
- primul strat de albus fluid
- al doilea strat de albus dens
- al doilea strat de albus fluid, in contact cu membrana cochiliera interna.
In jurul galbenusului, reprezentand aproximativ 2/3 din masa oului, se afla un strat de albumen in structura caruia se disting trei zone, produse probabil prin rotatia oului in oviduct. Albumenul are in compozitia sa numeroase proteine (peste 40 descoperite pana in prezent).
Inconjurand embrionul in dezvoltare, albumenul constituie o manta cu rol de a preveni deshidratarea acestuia si de a furniza substante necesare in ultima parte a dezvoltarii embrionare. Alte proteine din compozitia albumenului au roluri specifice: bactericide, enzimatice etc.
Albusul contine o cantitate mare de apa - 87 % si o serie de substante proteice
Proteinele din albus sunt reprezentate de:
- ovoalbumina - este principala proteina, care se gaseste in doua forme; una amorfa si una cristalina aceasta este reprezentata ponderal cu pana
La 70 % in oul proaspat si scade pe masura ce oul se invecheste, transformandu-se in ovoalbumina amorfa.
- ovoglobulina - o proteina cu structura globinica, ce favorizeaza schimburile de gaze dintre albus si galbenus sau dintre albus si camera de aer.
- glicoproteide - sunt substante proteice care contin in molecula si o grupare prostetica (ovomucina, ovomucoid).
3.1.3. MEMBRANELE COCHILIERE
Sunt alcatuite din proteine fibroase. Membrana cochiliera interna este mai groasa, adera la albus iar cea externa, foarte fina adera la coaja oului. Impreuna, cele doua membrane cochiliere au o grosime de aproximativ 70 ym. De asemenea, ele sunt aderente intre ele, cu exceptia portiunii de la varful rotund al oului, unde se formeaza camera de aer, care asigura schimburile gazoase intre ou si mediul exterior.
Din punct de vedere functional, membranele cochiliere asigura suportul morfologic pe care se realizeaza mineralizarea; fibre proteice din acestea penetreaza in profunzimea cojii, asigurand matricea organica a cojii mineralizate. De asemenea, membranele cochiliere se opun invadarii oului de catre bacterii.
Continut: CaCO3 - 94 %, MgCO3 - 1,2 % si fosfati in amestec cu o serie de substante organice - 4,8 %. Substantele organice sunt reprezentate in general de doua proteine (ovoprofirina si ovoxantina), care formeaza la exteriorul cojii o pelicula protectoare ce se distruge prin spalare sau prin invechirea oului.
3.1.4. CAMERA DE AER
Camera de aer se formeaza la capatul rotund al oului, intre membranele cochiliere, imediat dupa expulzarea oului, datorita contractiei continutului oului la diferenta de temperatura dintre corpul pasarii si mediul extern.
3.1.5. COAJA OULUI
Coaja oului are o grosime de aproximativ 350 y si are in compozitia sa cristale de calcita (carbonat de calciu). Perpendicular pe suprafata sa, coaja este strabatuta de numerosi pori care permit trecerea moleculelor gazoase.
De asemenea, coaja constituie o bariera fizica impotriva diferitelor substante care pot afecta micromediul embrionar, constituie suport mecanic pentru mentinerea orientarii componentelor interne ale oului si furnizeaza calciu embrionului.
Constitutia din stratul mamelonar bazal si stratul spongios extern este formata din cristale de carbonat de calciu, fiind groasa si rezistenta, dar in acelasi timp si permeabila pentru aer, gaze, vapori de apa. Are un rol deosebit de important in dezvoltarea embrionului.
3.1.6. CUTICULA
Cuticula este o membrana fina, formata din substante mucoproteice produse de vagin si uscate dupa expulzarea oului, cu rol de protectie antimicrobiana, fapt care explica masurile luate pentru pastrarea integritatii ei.
Cuticula are structura proteica si are rolul de a reduce pierderile de apa si de a preveni contaminarile bacteriene.
Din punct de vedere chimic, coaja oualor este formata in cea mai mare parte din carbonat de calciu (94 %), mici cantitati de carbonat de magneziu
(1,2 %) si fosfati, amestecate cu substante anorganice (4,4 %), formate din
ovoprofirina si ovoxantina.
In figura.2 este redata structura oului normal atat in sectiune longitudinala , cat si in sectiune transversala:

Figura 2 : Sectiune prin oul normal
a- sectiune longitudinala; b- sectiune tranversala; 1-latebra; 2- disc germinativ; 3- membrane vitelina; 4- vitelus galben; 5- vitelus alb; 6- primul strat de albus dens; 7- salaze; 8- primul strat de albus fluid; 9- al doilea strat de albus dens; 10- al doilea strat de albus fluid; 11- membrane cochiliera interna; 12- membrane cochiliera externa; 13- camera de aer; 14- coaja minerala; 15- cuticula; 16- stratul spongios de calcar; 17-porii cojii.
3.2. COMPOZITIA FIZICO-CHIMICA A OULUI
Oul constituie un veritabil tezaur de vitamine, acestea indeplinesc roluri esentiale in activitatea meatbolica. In situatii de carenta se declanseaza stari patologice specifice, numite avitamonoze. Pentru aceasta vom detalia fiecare caracteristica a vitaminelor existente in compozitia oului.
3.2.1. VITAMINA D (Calciferol)
Este vitamina antirahitica, sub aceasta denumire sunt incluse doua entitati cu formula chimica asemanatoare, respectiv vitamina D2 si vitamina D3.
Actiunea fiziologica a vitaminei D este strans legata de metabolismul calciului si fosforului. Referitor la calciu, se stie ca are un rol important din punct de vedere constitutional iar calciul ionic este esential pentru functia neuro musculara normala. Carenta in vitamina D, limiteaza mult absortia digestiva a calciului si fosforului care nu mai asigura mentinerea normala a bilantului calciului in circuitul metaboloic. In aceste conditii se produce mobilizarea calciului din depozitele osoase cu grave perturbari, in special la copii, cunoscute sub denumirea de rahitism iar la adulti sub denumirea de osteomalacie sau osteoporoza.
Continutul oului in vitamina D este de 150 u.i. %, fiind eficient in prevenirea carentelor. Cantitatea necesara pentru copii prin aport alimentar zilnic, se apreciaza la 400 u.i. vitamina D iar la adulti in jur de 130 u.i., exceptand starile fiziologice particulare (sarcina si lactatia).
3.2.2. VITAMINA B12 (Ciancobalamina)
Este factorul antipernicios, care previne instalarea anemiei pernicioase. Aceasta boala este o anemie macrocitara hipocroma, insotita de leucemie, tulburari nervoase (datorita unor leziuni ale maduvei spinarii) si tulburari gastrice in secretia de acid clorhidric. Anemia se datoreaza incapacitatii maduvei ososase de a produce globule rosii normale. In sangele circulant ele au forme primitive si viata foarte scurta.
Structura chimica este foarte complexa, in afara de cobalat, ea cuprinde si
un grup - CN de unde si denumirea de ciancobalamina.
Este socotita ca cea mai activa vitamina din toate cunoscute. O cantitate minima (1-2 micograme / zi), este suficienta pentru maturarea eritrocitelor si a celorlalte elemente figurate ale sangelui, precum si pentru integritatea functionala a sistemului nervos si a mucoasei tubului digestiv.
Se crede ca vitamina B12, este sintetizata de catre microorganismele din tractusul digestiv, de unde este absorbita si stocata in tesuturi, in special in ficat.
Necesarul pentru un adult se apreciaza la 2 micrograme pe zi. Oul contine in medie 0,4 micrograme %, deci, contribuie la asigurarea necesarului pentru aceasta vitamina.
3.2.3. VITAMINA B6
Este un derivat al piridinei, de unde deriva si denumirea de Piridoxina. Carenta vitaminica intereseaza pielea, sistemul nervos central si eritropoieza.. Vitamina B6 formeaza o grupare prostetica a sistemelor enzimatice cu rol fundamental in metabolismul aminoacizilor.
Leziunile cutanate, de tip seboreic, sunt localizate in special , in jurul ochilor si al gurii si pot fi insotite de stomatita si glosita.
Leziunile sistemului nervos central constau in degenerarea nervilor periferici a celulelor ganglionilor spinali din zona dorsala si a cordoanelor posterioare ale maduvei spinarii, exteriorizate prin contractii musculare clonice si crize convulsiforme. La nivelul sangelui, produc o anemie microcitara si hipocroma.
Continutul oului este de 0,3-0,4 mg %, necesarul fiind apreciat la 2 mg pe zi.
3.2.4. VITAMINA B2 (Riboflavina)
Intra in structura gruparii prostetice a unor enzime oxido-reducatoare, care au rol esential in metabolismul celular, avand in structura ei chimica si riboza. Semnele de carenta se instaleaza lent si constau in leziuni la nivelul corneei si al mucoasei bucale.
Necesarul zilnic pentru adult este de 2-2,5 mg. Continutul oului in riboflavina este in jur de 0,5 mg %.
3.2.5. VITAMINA B1 (Tiamina)
A fost prima vitamina din grupul B descoperita. Ea constituie coenzima carboxilazei si are rol important in metabolismul intermediar al glucidelor.
Carenta grava de tiamina, produce boala numita Beri-Beri. Tulburarile cele mai importante intereseaza sistemul nervos si cardiovascular. Semnele nervoase se exteriorizeaza prin senzatia de slabiciune din membre, mers titubant si chiar paralizia completa a unui membru.
Necesarul zilnic pentru om este estimat la 1-2 mg, oul continand 0,1-0,15 mg %.
Vitamina A (Axeroftol), are cel putin doua functii importante in organism:
un rol deosebit in perceptia vizuala si altul in protejarea celulelor epiteliele. Hipovitaminoza A, impiedica adaptarea vederii la intuneric, generand boala numita nictalopie sau orbire nocturna. Rolul esential al functiei vizuale este indeplinit de pigmentul fotosensibil din retina numit rodospina, in structura careia intra vitamina A.
Sursa vegetala de vitamina A se gaseste sub forma de provitamina, denumita beta-caroten, care in organismul animal se transforma in vitamina propriu zisa.Carenta prelungita de vitamina A la om, produce initial nictalopia (orbirea nocturna), deoarece in absenta ei nu mai poate fi sintetizat pigmentul fotosensibil din retina (rodopsira). Ulterior apare keroftalmina, caracterizata prin keratinizarea corneei, urmata de ulceratii.
Afectarea celulelor epiteliale ale tractusului respirator favorizeaza infectiile nazale si sinusale, precum si tulburari la nivelul traheei, bronhiilor si pulmonilor, cum ar fi astmul bronho-pulmonar.
Leziunile cutanate se exteriorizeaza prin uscarea si keratinizarea pielii, precum si aparitia de leziuni papulokeratinizate. Afectarea epitelului renal este insotita de formarea calculilor urinari multipli.
Nevoia de vitamina A este apreciata de 1.500 U.I. zilnic pentru copil mic si 5.000 U.I. pentru adult. Oul integral contine 1.000-4.000 U.I. % . Intrucat vitamina A este liposolubila, este concentrata in galbenus, unde continutul este mult mai mare decat oul integral.
3.2.6. VITAMINA K
Este un principiu esential pentru coagularea normala a sangelui. Actiunea fiziologica este legata de sinteza protombinei, care se produce in ficat. Carenta in vitamina K, genereaza hipoprotrombinemia, care impiedica coagularea normala a sangelui. Ea genereaza hemoragii in urma leziunilor sau contuziilor de orice fel, intrucat necesarul de vitamina K este asigurat prin ratia alimentara obisnuita si in plus ea este sintetizata si de flora microbiana intestinala.
3.2.7. VITAMINA E (Tocoferolul)
Se gaseste in stare libera in natura sau poate fi preparat prin sinteza.
Vitamina E, este vitamina antisterilitate, deci este necesara pentru asigurarea reproducerii normale la om si animale. In stari de carenta provocate la animalele de experienta, s-au constatat mai multe tulburari. La mascul, instalarea sterilitatii definitive datorita degenerescentei epiteliului germinativ, aceleasi perturbari se intalnesc si la ovarul femelelor.
Daca starea de carenta grava se instaleaza la femela gestanta, se produce moartea fatului si reabsorbtia continutului uterin.
Alte perturbari se refera la distrofia musculaturii striate si a miocardului.
Se apreciaza ca necesarul de vitamina E pentru om este de 30 mg pe zi. Ratia alimentara obisnuita poate asigura acest necesar, oul asigurand 2-3 mg %.
3.2.8. ACIZI GRASI ESENTIALI
Principala lor functie este cea plastica si energetica (sunt constituanti ai grasimilor), iar pe de alta parte ca indeplinesc si alta functie vitaminica importanta. Din aceasta cauza, acizii grasi esentiali au fost denumiti si cu termenul generic de vitamina F.
Carenta in acesti factori esentiali se exteriorizeaza prin oprirea cresterii, leziuni cutanate si renale, precum si tulburari in reproducere care pot ajunge pana la sterilitate.
Necesarul pentru om este apreciat la 6-15g pe zi, iar galbenusul contine 14-16 % acizi grasi esentiali.
3.2.9. PROTEINELE
Sunt reprezentate de ovovitelina si ovoalbumina si au cel mai echilibrat continut in aminoacizi, incat constituie standardul de referinta (notat cu 100), pentru aprecierea valorii biologice a celorlalte proteine.
In graficul nr 1 este redat continutul in aminoacizii - esentiali exprimat cantitate mg la 1g protide:

Grafic nr : 1
3.2.10. LIPIDELE
Sunt cantonate in galbenus si au o valoare biologica net superioara fata de grasimile animale sau vegetale. Ele sunt alcatuite din gliceride, deci grasime propriu-zisa (63 %), colesterol (2 %) si lipide derivate (2 %)
3.2.11. SUBSTANTELE MINERALE
Toate cele 18-19 elemente minerale din structura tesuturilor se regasesc in structura oului in mod echilibrat, asemanator cu trebuintele metabolice ale organismului uman.
Continutul de fosfor se situeaza la valoarea medie de 232 mg la 100g ou integral reprezentat in special in galbenus (63 mg %) si foarte putin in albus (16 mg %).
Valoarea medie a continutului de calciu este de 55 mg la 100g in oul integral, din care 131 mg % in galbenus si 14 mg % in albus. Valoarea raportului Ca/P este pronuntat subunitar, cu mult mai mica decat pentru mineralizarea oaselor.
Oul constituie o bogata sursa de fier (3 mg la 100g), deci, de cca. 30 de ori mai mare decat in lapte si are o contributie importanta la corectarea deficitului la multe produse alimentare.
Compozitia chimica a elementelor componente ale oului nu este insa fixa: ea depinde de timpul scurs de la ouat, rasa de pasari, ratia furajera etc.
Albusul este un lichid gelatinos, vascos, de culoare alba. Culoarea galbenusului variaza de la galben-deschis la galben-rosiatic. Pentru distingerea nuantei de culoare a galbenusului se foloseste spectrul de culoare Roche, care cuprinde 12 culori standard. Culorile de la 1-6 incep cu nuantele fildesului si merg pana la galben deschis. Culorile de la 7-8 au pigmentatia cea mai dorita a galbenusului. In continuare se gasesc culori de galbenusuri foarte intens pigmentate spre rosiatic.
pH-ul albusului este de 7.9, iar al galbenusului slab acid 6.0-6.2.
|
Componente |
Albus |
Galbenus |
|
Apa % | ||
|
Substante proteice % - din care % |
Ovoalbumina cristalizata 69.7 Ovoalbumina necristalizata 9.0 Ovoglobulina 6.7 Glicoproteide: - ovomucoide 12.7 - ovomucina 1.9 |
Ovovitelina 78.4 Lecitina, Liventina 21.5 Globuline: cantitati neinsemnate |
|
Lipide % |
Urme 0.03 |
Trigliceride 63 Fosfatide 33 - lecitina 8-11 - cefalina - colina Steride: colesterol |
|
Glucide % |
Urme |
|
|
Saruri minerale % |
- mai mult: K, Na, Cl - mai putin: Ca, P, Fe |
- mai mult: Ca, Fe, P, S - mai putin: Na, Al, Zn, Mn, Cu, Pb, Cl etc. |
|
Coloranti |
Ovoflavinei - asemanatoare vitaminei B2 |
Luteina (carotenoid): xantina zeaxantina |
|
Enzime |
Proteinaze - apropiate de pepsina |
Lipaze: tributiraza, metilbutiraza Proteinaze - autolitice Colinesteraze, diastaze |
|
Vitamine |
B2 - cantitati mici |
A, complex B, D, E, K |
Tabel nr. 3- Compozitia chimica a albusului si a galbenusului
3.3. ANALIZA MICROBIOLOGICA A OUALOR
Calea cea mai frecventa de infectare a oualor o reprezinta mediu extern (solul contaminat, cuibarul s.a.). De pe coaja oualor au fost izolate salmonele, coliformi, enterococi precum si bacterii apartinand genurilor: Pseudomonas, Proteus, Bacillus, Staphylococcus, Micrococcus sau mucegaiuri de genul Aspergillus, genul Penicilinum s.a.
Ca urmare a dezvoltarii microorganismelor in ou, are loc descompunerea protidelor cu formare de indol, amoniac, s.a., degradarea lipidelor cu eliberarea de acizi grasi.
Prin pastrarea oualor la temperatura camerei, alterarea cea mai frecventa o produc bacteriile din genul Proteus, iar prin pastrarea in conditii de refrigerare de catre bacterii din genul Pseudomonas. In analiza microbiologica a oualor se analizeaza microbiota cojii si a continutului sau.
3.3.1. ANALIZA MICROBIOLOGICA A COJII DE OU
La
capatul marit al oului, cu ajutorul unui bisturiu steril, se face un
orificiu de 3-
- Numar total de bacterii (NTG);
- Drojdii si mucegaiuri;
- Bacterii din genul Proteus, Salmonella (facultative);
- Bacterii coliforme.
ANALIZA MICROBIOLOGICA A CONTINUTULUI OULUI
Se mentine oul in alcool 70 % timp de 2 minute, se scoate pe capacul unei cutii Petri, si se da foc si se roteste pana se stinge flacara astfel incat sa se produca o sterilizare superficiala a cojii. Se face un orificiu in coaja, se scurge continutul intr-un vas steril si cu ajutorul unei pipete cu varful larg se fac recoltari din albus si galbenus, determinandu-se numarul de bacterii, drojdii si mucegaiuri si se testeaza prezenta bacteriilor din genurile: Pseudomonas, Salmonella, Clostridium perfrigens. Pentru punerea in evidenta a bacteriilor de putrefactie, se introduc probe de albus si galbenus in apa peptonata si dupa incubare 24 ore la temperatura de 35s C, se determina testele HIL.
In controlul sanitar a oualor se iau in considerare si observatiile facute cu ovoscopul, cu privire la integritatea cojii, marimea camerei de aer, prezenta mucegaiurilor sub coaja, aspectul albusului.
Ouale de calitate microbiologica corespunzatoare trebuie sa indeplineasca urmatoarele conditii:
- numarul total de germeni de pe coaja sa fie mai mic de 1.000.000 germeni / intreaga coaja.
- absenta salmonelelor de pe coaja
- absenta microorganismelor, inclusiv al salmonelelor in continut.
3.3.3. ANALIZA MICROBIOLOGICA A PRAFULUI DE OU
Praful de ou nu este un produs steril. Calitatea sa microbiologica depinde de calitatea materiei prime si de conditiile igenico-sanitare in timpul procesului de fabricatie. Pentru analiza se cantaresc 5g proba si se omogenizeaza cu 45 ml ser fiziologic steril si din dilutii decimale se fac insamantari pentru NTG, bacterii coliforme, bacterii din genurile Proteus si Salmonella. Se apreciaza ca numarul total de germeni / g trebuie sa fie sub 15.10(6) / g, iar bacteriile psihofile, dupa cultivare in mediu TEGA si pastrare la 0s C, timp de 72 ore, trebuie sa fie in numar mai mic de 3.10(5) / g.
Bacteriile coliforme se impune sa fie absente 0,001g. Pentru stabilirea calitatii
igienico-sanitare a prafului de ou, se fac determinari conform normelor in viguare in tara noastra si produsul trebuie sa indelineasca urmatoarele conditii:
. Numarul total de germeni aerobi mezofili: max. 100.000 / g
. Bacterii coliforme: max. 10 / g
. Salmonella: absent 50 / g
. Stafilococ auriu coagulazo-pozitiv: max. 1 / g
. Drojdii: max. 10 / g
. Mucegaiuri: max. 10 / g
CAPITOLUL IV
ELEMENTE DIFERITIALE ALE OUALOR PROVENITE
DE
4.1. OUALE DE PREPELITA
Ouale de prepelita au valoare alimentara superioara celor de gaina (in proteine, grasimi, vitamine), sunt dietetice si sunt recomandate medical. Coaja trebuie sa aibe pete rosii-maronii, purpurii si negre pe fond cenusiu deschis, cu lustru si culoare proaspata si coaja rezistenta. Ouale cu coaja putin rezistenta, de culoare brun deschisa, alb sau albastra si forma neobisnuita sunt produse de pasari bolnave sau batrane si nu sunt de calitate. Greutatea oualor trebuie sa fie de 10-12g, iar la spargere sa prezinte un galbenus de culoare galben intens si un albus vascos si lipicios. Ouale de prepelita trebuie valorificate proaspete pentru ca avand coaja subtire, continutul in apa se evapora relativ repede, calitatea oului deteriorandu-se.
La rasa franceza (Susa), ouale au un
desen specific, sunt lungi de
Componentele oului de prepelita vor fi redate in tabelul urmator:
|
Componente |
Greutate grame |
% din total ou |
|
Greutate totala din ou din care: albus galbenus | ||
|
Coaja |
Tabel nr. 4- Greutatea si componentele oului de prepelita
Figura nr. 3 -Valoarea nutritiva a oualor de prepelita
Actiunea farmacoecologica :
- Ooale de prepelita imbunatatesc functionarea inimii ;
- au un effect benefic asupra bolilor cu localizare la nivelul rinichilor si a
ficatului ;
- ajuta digestia, regleaza acidul gastric, vindeca ulcerul ;
- improspateaza si intareste memoria ;
- este eficient in reglarea sistemului nervos, in vindecarea afectiunilor
cardiace si pulmonare .
4.2. OUALE DE PREPELITA -REMEDII NATURALE
Medicina traditionala chinezeasca recomanda ca sigure trei remedii, care pot fi considerate adevarate elixiruri de viata lunga si anume: radacina de ging-seng, veninul de vipera si renumitele oua de prepelita. Acestea din urma, un adevarat miracol, revitalizeaza organismul uman, fiind foarte bine venite atat in cazul copiilor, cat si in cazul adultilor.
Medicii cercetatori japonezi si americani experimenteaza in clinici si sanatorii eficacitatea medicala a oualor de prepelita. Potrivit specialistilor, odata inceputa cura, are loc o imbunatatire a activitatii inimii, ouale de prepelita avand un efect deosebit si asupra ficatului si a rinichilor, ajutand in procesul digestiei, regland secretia sucurilor gastrice, vindecand chiar si ulcerul, improspatand si intarind memoria si fiind extrem de folositoare pentru dezvoltarea armonioasa a copiilor mici, precum si pentru improspatarea organismului atat la adulti cat si la copii.
Tratamentul cu oua de prepelita este recomandat pentru cazurile in care organismul uman a fost supus pentru o perioada indelungata de timp unui regim alimentar sever.
Cura de 120 oua
Se recomanda celor care sufera de hipertensiune, ulcer si tulburari digestive. Se pot administra timp de 25 zile in urmatoarea cadenta : 3 oua in prima si a doua zi, 4 oua in a treia zi, 5 oua in urmatoarele zile pana in ziua a 25-a.
Cura de 240 oua
Se recomanda celor cu afectiuni generate de aterosleroza, diabet,TBC,anemie, migrene, boli de ficat si de rinichi, pentru curatarea tenului. Cura dureaza 49 zile si se administreaza la fel ca si in cazul celei de 120 de zile.
Dupa 20 zile de pauza, cura poate fi reluata, oul de prepelita fiind un ou dietetic.
4.3. OUALE DE RATA SI GASCA
Este greu sa se obtina oua cu coaja curata fiindca ratele sunt indiferente in ceea ce priveste ouale. Unele le lasa in gropi sau pe unde se nimereste. Asternutul ud si cu dejectii murdareste ouale iar germenii patrund in ele.
Productivitatea oului la rase ouatoare speciale cum ar fi cele de la crescatoria
"Cherry Valley", Khaki Campbell si rata alergatoare indiana cu un potential de 270 de oua in 52 de saptamani este foarte aproape de productivitatea gainilor.
Ouale de rata sunt folosite mai ales la copt si la gatit, de aceea sunt foarte apreciate pretutindeni. O comparatie intre ouale de rata si cele de gaina ne arata ca ratele au:
- 0.6 % mai multe proteine, in total 13.5 %
- 3.6 % mai multa grasime, in total 14.5 %
- 3.9 % mai multa substanta uscata, in total 30.3 %
Procentual, ele sunt deci mai bogate in substante nutritive decat ouale de gaina, tinand cont si de faptul ca ele sunt cu circa 25 % mai grele.
Din cauza incidentelor neplacute din Germania (dupa primul razboi mondial), datorita infectiei cu Paratifos prin intermediul oualor de rata, au fost restrictionate vanzarile si consumul de oua de rata.
Este obligatoriu sa fie inscriptionate cu aceasta informatie toate ouale de rata.
Un ou
de gasca are circa
Pentru consumul uman sunt foarte indicate ouale de gasca, dar din cauza productiei mai reduse de oua, preturile sunt mult mai mari iar rentabilitatea mai slaba. Nu exista prevederi legale referitoare la vanzarea oualor de gasca.
4.4. OUALE DE FAZAN
Ouale fazanilor sunt foarte slabe si au un invelis fragil, de aceea trebuie sa se umble cu foarte mare atentie cu ele, in special atunci cand pasarile sunt crescute in voliere. Ouale adunate sunt marcate prin inscrierea initialei rasei si data ouarii.
Ouale de fazan au culoare verzuie, uniforma, greutatea lor variind intre 30-35g.
Unii crescatori acorda o importanta deosebita culorii cohiliei astfel ouale mai pigmentate, sunt in general mai putin fertile. Ouale produse la inceputul sezonului sunt prea mici, cu forme anormale si cu coaja rugoasa. Abia dupa 4-6 ouari se obtin ouale cu greutate si aspect normal.
|
Specie |
Greutate in grame |
Partea galbenusului in % |
Partea albusului in % |
Coaja in % |
|
Gasca | ||||
|
Curca | ||||
|
Rata | ||||
|
Gaina | ||||
|
Porumbel |
Tabel nr . 5- Greutatile medii ale oului si ale partilor componente
(prezentare comparativ)
PARTEA A II- A
CERCETARI PERSONALE
CAPITOLUL V
CONTROLUL CALITATII OUALOR DE CONSUM
Aprecierea calitatii oualor se face pe loturi, prin lot intelegandu-se cantitatea de oua de aceeasi categorie si clasa, care se livreaza odata aceluiasi beneficiar, in ambalaje de acelasi fel. Se ia la intamplare din fiecare lot 10 % din numarul lazilor.
In reteaua comerciala se livreaza urmatoarele categorii de oua in functie de prospetime:
- oua foarte proaspete sau dietetice, cele care au o vechime de maxim 5 zile de la data ouatului;
- oua proaspete: acestea sunt transparente, iar lumina trece usor prin ele. Albusul are culoare alba spre roz deschis, iar galbenusul de la galben deschis pana la rosiatic. Ca pozitie, galbenusul este sferic, asezat central si bine separat de albus. Camera de aer este mica si imobila. Sunt considerate oua proaspete cele ce au:
au o vechime de 10 zile in perioada 31 Martie - 15 Septembrie
au o vechime de 20 zile in perioada 15 Septembrie - 31 Martie
- oua conservate marcate cu CF in cazul conservarii prin frig sau cu C in cazul conservarii prin alte mijloace.
Compozitia cimica si repartizarea neuniforma a elementelor chimice, face ca partile comestibile ale oului sa fie deosebit de instabile, fiind supuse, din momentul producerii, la modificari continue.
Ouale proaspete sunt lipsite, de obicei, de microorganisme. Modificarile fizico-chimice incepute sub actiunea enzimelor din galbenus si albus sunt intensificate de microorganismele care pot patrunde in interiorul oului pe masura invechirii. Proportia oualor care contin bacterii in interior este de 2-5 % pentru cele proaspete si de 10-15 % pentru cele vechi.
Sub influenta enzimelor proteoloitice si acidoaminolitice din bacteriile ce patrund in ou, proteinele din albus si apoi cele din galbenus se lichefiaza si cu timpul, cele doua componente se amesteca, capatand un aspect tulbure. Datorita pigmentilor elaborati de microorganisme, continutul oului se coloreaza in verde, rosu sau negru.
Ovomucina din partea densa a albusului se lichefiaza, punandu-se in libertate apa care trece in partea lichida a albusului. Ovoalbumina cristalizata trece in stare amorfa. Salazele iau aspect de portelan si se lichefiaza, membrana vitelina se autolizeaza, drept urmare galbenusul nu mai este mentinut in pozitie centrala si se deplaseaza spre coaja.
Daca este pus pe o suprafata plana se lateste. In coaja oualor scade cantitatea de ovoprofirina. Astfel, in timp ce ouale proaspete examinate la lumina ultravioleta dau o florescenta rosie, ouale vechi sunt violet - albastre.
Prezenta a numeroase substante rezultate din descompunerea aminoacizilor (NH3, NH2, mercaptani, diverse amine etc.), confera oualor un puternic miros de putrefactie si face ca ele sa fie foarte periculoase pentru consumatori.
Diversele tipuri de alterari ale oualor se produc in raport cu microorganismele in cauza si cu conditiile de pastrare. Astfel, in ouale pastrate la temperatura camerei se dezvolta bine si este frecvent intalnit genul Proteus.
Pastrarea la frigorifer, favorizeaza dezvoltarea microorganismelor psihrofile, cum sunt cele din genul Pseudomonas.
Prezenta germenilor din genul Pseudomonas in oua, nu se poate remarca organoleptic de la inceput, alterarea apare dupa 35 zile de la pastrare la rece si poarta diferite denumiri:
5.1.1. PUTREFACTIA VERDE
Oul de culoarea ierbii, ou ocru, ou fluorescent ocru etc. Examenul ovoscopic obisnuit nu deceleaza la inceput modificarile. De aceea, ouale se vor examina la lumina ultravioleta Wood, cand, datorita disparitiei ovoprofirinei din coaja, vor capata culoarea violet-albastruie. Mai tarziu, albusul devine apos, se coloreaza in verde si castiga miros de branza sau varza alterata. Intr-un stadiu si mai avansat, albusul se amesteca cu galbenusul, substantele proteice se degradeaza si prin descompunere pun in libertate indol, scatol, NH3, NH2 etc. Glucidele fermenteaza, iar lipidele se hirolizeaza si pun in libertate acizi grasi.
5.1.2. PUTREFACTIA GAZOASA (fecaloida)
Este produsa de Bacillus mezentericus, continutul oului ia o culoare galben-caramiziu, cu consistenta vascoasa si miros de branza.
5.1.3. PUTREFACTIA NEAGRA
Este produsa in specie de Proteus melanovogenes, in asociere cu Escherichia coli, Alcaligenes, Aerobacter aerogenes, etc.
Albusul si galbenusul se amesteca, devin fluide, au o culoare brun-negricioasa, emana un miros intens, datorita mai ales degradarii de hidrogen sulfurat.
5.1.4. PUTREFACTIA ROSIE
Este produsa de unele specii ale genului Sarcina sau Pseudomonas. Unele specii ale genului Alcaligenes produc alterari ale oualor fara modificari de culoare, in timp ce altele (Alcaligenes boockeri), produc putrefactii, modificand continutul in verde si galben.
Bacteriile coliforme contribuie uneori, la alterarea oualor. Cand unele tipuri de bacterii coliforme se inmultesc in albus, acesta capata miros de peste. Alte specii bacteriene, cum este Achromobacter perolens, produce in ouale alterate miros de mucegai.
5.1.5. ALTERAREA PRIN MUCEGAIRE
Sporii mucegaiurilor din diverse genuri (Cladosporium, Penicillium, Mucor, Aspergillus, Thamnidium, Sporotrichum, etc.), in conditii de umiditate marita (din ambalaje sau camera de depozitare), patrund in spatiu dintre coaja si membrana cochilifera si dezvolta colonii. Alterarea prin mucegaire la oua, apare la ovoscop ca spoturi, pete colorate pe fata interna a cojii si pe galbenus. Mucegaiurile favorizeaza patrunderea bacteriilor in interior. La inceput exista mirosul numai de mucegai, dar ulterior, apar si alte modificari care duc la alterarea continutului. Uneori galbenusul adera la coaja (galbenus fix).
Modificarile alterative ale oualor pot fi diminuate sau eliminate total daca se respecta parametrii fluxului tehnologic in conditii de igiena, incepand cu aeromicroflora din halele de pasari, igiena pasarilor din halele de ouat, conditiile de recoltare, manipulare, sortare, ambalare, transport si depozitarea oualor.

Figura nr . 4- Diferite tipuri de mucegaiuri
Dupa greutate ouale de gaina pentru consumul alimentar, se clasifica in:
- oua mari, de peste 50g.;
- oua mijlocii de 40-50g.;
- ouale cu greutate sub 40g - se livreaza la kilogram numai unitatilor industriale, la cele de alimentatie publica si pentru consumul colectiv.
Aprecierea calitatii oualor se face prin metode de examinare pe oul ca atare si prin metode de examinare pe oul spart.
Pentru inmultire si dezvoltare, microorganismele au nevoie de material plastic azotat. Acesta este preluat din stratul nutritiv, dupa o prealabila proteoliza.
Proteoliza este un proces chimic de simplificare, care este catalizat enzimatic. Enzimele proteolitice din oul in curs de invechire au o dubla origine, una intrinseca, proprie structurii naturale a oului si alta extrinseca, proprie microorganismelor de contaminare. Intre modul de actiune a celor doua antagonii de enzime exista deosebiri importante. Cunoasterea mecanismului de actiune este necesar pentru interpretarea corecta atat a starii de invechire, cat si a celei de alterare.
Molecula proteica este alcatuita din inlantuirea unui numar mare de aminoacizi. Unirea lor nu se face la intamplare, ci intotdeauna dupa aceeasi regula si anume prin legarea gruparii aminice a unui aminoacid (-NH2), cu gruparea carboxilica a celuilalt aminoacid (-COOH), care se realizeaza cu eliminarea unei molecule de apa. Rezulta astfel, o legatura specifica numita legatura peptidica (NH-OC):
Proteoliza se realizeaza exact dupa aceeasi regula, dar in sens invers, prin aditionarea unei molecule de apa la nivelul legaturii peptidice prin care molecula peptidica se desface in doua fractiuni peptidice. Fiecare fractiune este simplificata in continuare dupa aceeasi regula.
Intre modul de actiune ale enzimelor proteolitice intrinsece si cel al enzimelor microbiene, exista deosebiri. Enzimele intrinsece sunt endopeptidaze. Ele ataca legatura peptidica din interiorul lantului molecular proptidic.In felul acesta, din molecula protidica initiala rezulta o multime de molecule peptidice, din ce in ce mai mici. Teoretic, ar insemna ca actiunea enzimelor proteolitice intrinsece s-ar finaliza prin eliberare de aminoacizi. Practic insa nu se ajunge la acest stadiu, datorita actiunii concomitente ale enzimelor proteoloitice extrinseci de natura microbiana.
Enzimele proteolitice si peptidolitice de natura microbiana sunt exopeptidaze. Ele ataca prima legatura peptidica de la extremitatea lantului molecular. Rezulta ca in cursul activitatii incipiente se elibereaza aminoacizi, astfel numarul molecular de aminoacizi in stare libera creste proportional cu intensitatea proteolizei microbiene.
Microorganismele au si capacitatea de a elabora o categorie specifica de enzime numite acidaminolitice, cu ajutorul carora descompun in continuare aminoacizii pana la cele mai simple combinatii chimice (CO2, NH3, H2S), din care isi vor sintetiza propria substanta.
Descompunerea incepe intotdeauna de la extremitatea lantului molecular, prin desprinderea pe rand a celor doua grupari reactive (NH2 si COOH).
Bacteriile anaerobe elibereaza enzime care descompun in mod preferential
aminoacizii din seria ciclica. Daca descompunerea incepe prin decarboxilare,din aminoacidul angajat rezulta o molecula de amino si una de bioxid de carbon. Toate aminele rezultate din decarboxilarea aminoacizilor care apartin seriei ciclice sunt potential toxice.
Schema decarboxilarii acestor aminoacizi este urmatoarea:




Daca descompunerea incepe prin dezaminare, in toate cazurile, indiferent de mecanismul reactiei chimice (reducere, oxidare sau hidroliza), se elibereaza amoniac si dupa caz, acizi organici simpli, cetoacizi sau hidroacizi:



Activitatea enzimelor acidaminolitice produse de bacteriile anaerobe nu se opreste la stadiile mentionate si continua cu numeroase reactii chimice pana la stadiul final. Deasemenea, pe langa descompunerea minoacizilor din seria ciclica, ele au aceeasi afinitate si pentru aminoacizii care contin sulf in structura lor moleculara. Pe traseul lantului de descompunere rezulta o multime de produsi chimici cu miros respingator pronuntat:



METODE DE EXAMINARE PE OUL CA ATARE
5.2.1. EXAMENUL EXTERIOR AL OULUI
Se refera la aprecierea culorii , la aspectul cojii, la prezenta unor eventuale crapaturi sau deformari al cojii.
Culoarea cojii - variaza in functie de specie, de rasa si poate fi: alba, galbena - deschis, galben -inchis sau chiar cafenie. Ouale de rata au culoarea cojii alba, verde dechis, verde -albastrui sau verde -inchis. Ouale de gasca au o culoare alb mata, fara luciu . Ouale de curca au coaja galbuie cu stropi galbui- cafenii.
Coaja oului proaspat are un aspect rugos cu porii vizibili, cel vechi are coaja lucioasa, uneori cu pete, porii nefiind vizibili. Ouale la care coaja prezinta anomalii sau crapaturi se sorteaza la categoria (oua cu defecte).
Curatirea cojii se admite numai cu masini speciale, nefiind permisa spalarea oualor proaspete indiferent de destinatia lor.
Figura nr. 5 - Examinarea exterioara a oului
Figura nr. 6 - Examinarea exterioara a oului - detaliu marcare
5.2.2. EXAMENUL OVOSCOPIC- PROBA MIRAJULUI
Proba consta in examinarea transparentei oului, la un fascicol de lumina
Principiul metodei:
Examinarea se realizeaza cu ajutorul ovoscopului , cel mai simpul este realizat dintr-un cilindru de tabla, in interiorul caruia se introduce o sursa de lumina. In dreptul sursei de lumina, cilindrul are una sau mai multe orificii cat dimensiunea unui ou. Cele doua orificii sunt prevazute cu un dispozitiv metalic, cu care se masoara in acelasi timp si inaltimea camerei de aer.
In urma examenului ovoscopic ouale se clasifica in :
- oua foarte proaspete sau dietetice;
- oua proaspete;
- oua conservate.
Ouale proaspete sunt transparente si prezinta albusul de culoare alba, spre roz deschis, iar galbenusul de culoare galbena deschis pana la rosiatic.
Camera de aer este mica si imobila. Ouale vechi devin tulburi sau chiar opace, separarea dintre albus si galbenus dispare.Camera de aer se mareste, devine mobila, salazele se rup, galbenusul devine mobil, uneori fixandu-se pe partea interna a cojii. Intr-un stadiu mai avnsat de invechire a oului, se poate observa pe fata interna a cojii pete de culoare inchisa, produse de diferite mucegaiuri sau bacterii.

Tipuri de ovoscoape imaginea 1 si 2 ;
Dispozitiv pentru masurat camera de aer; Figura nr : 6- Tipuri de ovoscoape
|
Categoria |
Oua foarte proaspete |
Oua proaspete |
Oua conservate |
|
Camera de aer (inaltimea maxima) |
|
|
1/5 din inaltimea oului |
|
Albus |
transparent - dens |
transparent, foarte putin fluid |
putin fluid |
|
Galbenus |
compact, central, fara contur precis, foarte putin mobil. |
compact, vizibil, foarte putin mobil |
compact, vizibil mobil |
Tabel nr. 6- Clasificarea oualor in urma examenului ovoscopic
5.2.3. EXAMENUL CU RADIATII ULTRAVIOLETE(Lampa lui WOOD)
Examenul consta in proprietatea ovoprofirinelor de a modifica culoarea albastra - violet a radiatiilor ultraviolete in rosu.
Principiul metodei:
Principiul consta in expunerea oualor la un fascicul de radiatii ultraviolete.
Coaja oualor proaspete contine un pigment: ovoprofirina, care dispare pe masura ce oul se invecheste.
Ovoprofirina are proprietatea de a vira culoarea albastra - violet a radiatiilor UV in rosu, astfel ca in cazul trecerii oului proaspat prin dreptul unui fascicol de radiatii UV acesta se coloreaza in rosu, iar cele vechi raman colorate albastru - violet.
In functie de invechirea oului se pot obtine nuante de culoare de la rosu la albastru - violet. Examenul nu furnizeaza relatii referitoare la modificarile continutului oului.
5.2.4. PROBA DENSITATII
Se bazeaza pe scaderea densitatii oului odata cu invechirea sa. Densitatea oului proaspat este in medie de 1,080, dupa 21 de zile ea poate ajunge la 1,050 sau chiar mai putin. Proba se poate efectua in apa obisnuita sau in apa sarata.
Proba in apa obisnuita:
Consta in introducerea oualor din proba de examinat pe rand intr-un vas cu apa cu fundul plat. In functie de pozitia oului in vasul cu apa si de marimea unghiului format intre axul longitudinal al oului si fundul vasului se apreciaza starea de prospetime a oului.
Interpretare:
- oul proaspat pana la 4 zile ia pozitia orizontala cu axul sau longitudinal paralel cu fundul vasului;
- cu cat oul se invecheste, cu atat axul sau tinde spre verticalitate, astfel ca la 30 zile formeaza cu fundul vasului un unghi de 90;
- ouale care au peste 30 zile se ridica la suprafata apei.
De la 4 la 30 zile vechimea oului se apreciaza dupa marirea unghiului format intre axul longitudinal al oului si fundul vasului astfel:
- la 7 zile formeaza un unghi de 20-25;
- la 15 zile formeaza un unghi de 45;
- la 21 zile formeaza un unghi de 75.

Ou din prima zi Ou de 8 zile Ou de 15 zile Ou are 1 luna
Figura nr. 7-Proba in apa obisnuita
Proba in apa sarata:
Consta in introducerea oualor intr-un vas cu solutie de 12% NaCl, urmarindu-se pozitia acestora (care este verticala) fata de partea inferioara a vasului si partea superioara a apei. Prin aceasta metoda se poate aprecia vechimea oualor pana la 8 zile.
Interpretare:
- la 1-3 zile, oul are pozitie verticala, atingand cu varful ascutit fundul vasului;
- la 3-5 zile, oul in pozitie verticala pluteste intre doua ape, la egala distanta intre fundul vasului si suprafata apei;
- la 6-7 zile, oul tot in pozitie verticala atinge cu varful bont suprafata apei, depasind-o cu atat mai mult cu cat este mai vechi.

Ou din prima zi Ou de 2 zile Ou de 3 zile Ou de 4 zile
Figura nr. 8-Proba in apa sarata
5.3. METODE DE EXAMINARE PE OUL SPART
Examinarea oului spart se indica ori de cate ori nu se poate stabili prospetimea prin metode ce nu necesita spargerea. In cadrul acestui grup de metode includem:
5.3.1.EXAMENUL ORGANOLEPTIC AL CONTINUTULUI OULUI
In acest scop oul se sparge intr-o placa Petri, unde se apreciaza mirosul, aspectul, culoarea si consistenta fiecarei componente. La oul proaspat mirosul este caracterisitic, albusul de culoare alba cu nuanta usor albastruie, cu consistenta usor gelatinoasa; galbenusul este de culoare galbena (diferite nuante) si are forma specifica. La oul vechi se constata un miros de statut, de mucegai sau chiar ranced, de hidrogen sulfurat sau putrid (daca sunt prezente procese de alterare). Albusul in acest caz este lichefiat si de culoare cenusiu - verzuie; galbenusul ia o culoare maslinie, pana la negru-verzui, isi pierde forma sferica si consistenta, amestecandu-se cu albusul.

Figura nr . 9- Examenul organoleptic al oului
5.3.2 . APRECIEREA VASCOZITATII ALBUSULUI
La oul proaspat exista doua straturi perviteline de albus dens si unul fluid, astfel incat intre acestea exista un raport cantitativ de 2/1. Pe masura ce oul se invecheste albusul se lichefiaza, iar acest raport se inverseaza devenind sau chiar mai mic, cantitatea de albus fluid crescand in detrimentaul albusului dens.Pentru aprecierea vascozitatii albusului, acesta se trece prin site foarte fine prin care trece partea fluida, iar cea densa este retinuta. Se cantareste cantitatea filtrata si cea retinuta, stabilandu-se raportul dintre cele doua volume.
5.3.3 . APRECIEREA PUTERII DE CRISTALIZARE A ALBUSULUI
Metoda se bazeaza pe proprietatea ovalbuminei din albusul oului proaspat de a cristaliza in contact cu aerul. Pe masura ce oul se invecheste ovalbumina se transforma in ovalbumina amorfa, pierzandu-si proprietatea de cristalizare.
In acest scop se intinde pe o lama de sticla o picatura de albus si se expune la aer, dupa care se examineaza la microscop.In cazul oului proaspat albumina cristalizeaza iar daca oul este vechi, cristalizarea este absenta.
5.3.4 . DETERMINAREA INDICELUI VITELINIC
Indicele vitelinic reprezinta raportul dintre inaltimea si diametrul galbenusului pus pe o suprafata plana.
Indicele vitelinic = h/d
Masurarea diametrului ( d ) si a inaltimii ( h ) galbenusului se face cu ajutorul unui subler.
.
Determinarea indicelui vitelinic

Figura nr. 10- Modul de calculare a indicelui vitelinic
Interpetare :
la oul proaspat indicele vitelinic este 1/2
la oul vechi 1/3 sau 1/4, datorita aplatizarii galbenusului in urma proceselor de autoliza ale membranei perivitelinice.
Figura nr. 11 - Determinarea indicelui vitelinic

Figura nr. 12 - Determinarea indicelui vitelinic
5.3.5. DETERMINAREA PH-ului
Se face cu hartie indicator universal sau prin metode electromagnetice, atat pentru albus cat si pentru galbenus precum si pentru amestecul de albus cu galbenus.
Albusul la oul proaspat are pH alcalin ( 7,8-8,2 ), pe masura ce se invecheste alcalinitatea creste.
Galbenusul la oul proaspat are pH-ul in jur de 6 , iar pe masura ce se invecheste tinde spre 6,8-7,0.
5.3.6. EVIDENTIEREA FOSFATILOR LIBERI
La ouale vechi din cauza schimburilor de substante intre albus si galbenus, ca rezultat al modificarii presiunii osmotice se pun in libertate fosfati ce pot fi pusi in evidenta.
Reactivi: - solutie de hidrochinona (
concentrat + apa distilata pana la 100 ml);
- molibdat de amoniu (
sulfuric 1N );
- solutie de carbonat si sulfit de sodium ( 100 ml de solutie de
carbonat de sodiu 20 % si 25 ml de solutie de sulfit de sodiu
15 % ).
Tehnica de lucru :
Intr-un pahar Berzelius se pun 2 ml albus peste care se adauga 8 ml apa distilata, proaspata, 5 ml de solutie de hidrochinona si 5 ml de solutie de molibdat de amoniu. Amestecul se lasa in repaus, iar dupa 5 minute se adauga 25 ml din solutia de carbonat si sulfit de sodiu, dupa care se apreciaza culoarea.
La ouale proaspete pana la doua saptamani, culoarea amestecului ramane neschimbata. La ouale vechi se observa o culoare albastra-verzuie care poate ajunge pana la albastru inchis, denotand prezenta fosfatilor liberi in albus.
In urmatorul tabel sunt redati parametri calitativi ai oualor de consum :
|
Caracteristici |
Oua foarte proaspete |
Oua proaspete |
Oua conservate |
|
Coaja |
Integra, rugoasa cu porii vizibili |
||
|
Camera de aer inaltime maxima |
|
|
1/5 din inaltimea oului |
|
Albusul |
Transparent, dens |
Transparent, foarte putin fluid |
Putin fluid |
|
Galbenusul |
Compact, central fara contur precis, foarte putin mobil |
Compact, vizibil,putin mobil |
Compact, vizibil, mobil |
|
Miros si gust |
Caracteristic oului proaspat, fara miros si gust strain |
Miros si gust specific procedeului de conservare |
|
|
Proba densitatii in apa de robinet |
Pozitie orizontala la fundul vasului |
Formeaza fata de fundul vasului un unghi de 25-75 gr |
Se comporta diferit in functie de vechime |
|
Proba densitatii in apa sarata 12 % |
Sta vertical la fundul vasului |
Atinge cu varful bont suprafata apei |
Depaseste mult cu varful bont suprafata apei |
|
Comportamentul la lumina lui Wood |
Se coloreaza in rosu | ||
|
Grade de vascozitate al albusului | |||
|
Puterea de cristalizare a albusului |
Albusul cristalizeaza in contact cu aerul |
Albusul isi pierde puterea de cristalizare |
|
|
Indicele vitelinic | |||
|
p H- ul albsului |
Peste 8,2 |
||
|
p H - galbenusului |
Peste 6,0 |
||
Tabel nr. 7- Analiza comparativa a gradului de prospetime
CAPITOLUL VI
DINAMICA CONSUMULUI DE OUA
PE PLAN MONDIAL
Unul dintre indicatorii cei mai sugestivi ai cresterii nivelului de trai al unei tari il reprezinta alimentatia. Paralel cu ridicarea standardului de viata si cu diversificarea alimentelor folosite de om, statisticile inregistreaza o descrestere a consumului de calorii pe locuitor si o sporire a consumului de proteine, vitamine, oligoelemente. In ceea ce priveste consumul de proteine se remarca nu numai o crestere cantitativa, dar si o imbunatatire calitativa reflectata mai ales in tendinta de a spori continuu proportia proteinelor de origine animala.
Oul, impreuna cu laptele, reprezinta singurele alimente complete. Din punct de vedere al valorii biologice generale, oul este superior laptelui, lucru explicabil prin faptul ca substntele continute sunt menite sa asigure, in cele mai potrivite proportii, tot ceea ce este necesar dezvoltarii embrionare precum ca si rezerve in organismul puiului.
Oul este clasificat intre cele mai importante alimente, datorita unor insusiri specifice, dintre care cele mai importante sunt:
- ouale pot fi utile in medicina umana datorita usurintei cu care sunt imbogatite in vitamine si microelemente prin tehnologii de alimentatie adecvata a pasarilor (oua vitaminate, oua iodate);
- conservabilitatea vitaminelor in ou este remarcabila atat la fierbere cat si la depozitare indelungata in spatii frigorifice;
- digestibilitatea oului in alimentatia omului este comparabila cu cea a laptelui, respectiv la galbenus 100% si la albus 97%
Datorita cotei deosebit de mare de participare la aprovizionarea omenirii cu proteina de cea mai mare valoare biologica, la care se adauga continutul ridicat in vitamine si saruri minerale ale oului - aliment indispensabil - ca si contributia la satisfacerea cerintelor de diversificare a alimentatiei umane.
S-a stabilit ca atunci cand consumul specific pentru un ou scade sub 150 gr. iar greutatea medie a oului creste peste 55 gr., consumul de proteina pentru producerea unui kg. de oua se apropie de consumul de proteina pentru producerea unui kg. de carne.
Spre deosebire de carnea de pasare considerata dietetica, mai ales carnea de piept, ouale au de infruntat o intensa campanie anticolesterol, campanie care chiar daca nu s-a incheiat, totusi a limitat consumul de oua in tarile dezvoltate si chiar a determinat o scadere a consumului de oua in unele tari foarte mari consumatoare.
Productia numerica de oua a inregistrat o crestere continua si constanta de
2 - 3 % anual. Astfel, la nivel mondial productia globala de oua a crescut de la 31 milioane de tone in 1995 la nivel estimat in 2007 cu putin peste 42 milioane de tone.Cea mai puternica ascensiune a productiei de oua in ultimii zece ani se inregistreaza in Asia, ceea ce se poate observa si in urmatorul grafic:

Grafic nr. 2 - Productia de oua pe plan mondial
Principalul motiv al acestei cresteri il reprezinta China, unde productia ultimului an a ajuns la 12,5 milioane de tone, adica aproximativ 30% din productia mondiala.
Comertul international de oua continua sa fie dominat de Olanda, urmata indeaproape de Belgia. Printre tarile mari exportatoare de oua se numara: China, Belgia, Franta si Malaezia.
Cea mai mare importatoare de oua din lume este Germania care participa la importul mondial cu aproximativ 50%.
In urmatorul grafic sunt puse in evidenta primele 10 tari producatoare de oua:

Grafic nr. 3 - Productia de oua pe plan mondial
CAPITOLUL VII
7.1. RECOLTAREA PROBELOR PENTRU EXAMENUL DE LABORATOR
Pentru examenul de laborator, probele se pot recolta direct din intreprinderile producatoare, depozite, mijloace de transport, reteaua de desfacere, iar in cazurile speciale, chiar la domiciliul cumparatorului sau producatorului.Aceastea trebuie sa oglindeasca cat mai fidel lotul din care provin.
Numarul de probe trebuie sa fie direct proportional atat cu marimea cat si cu gradul de neuniformitate al lotului respectiv.Transportul la laborator trebuie facut cat mai urgent si in conditi care sa nu modifice calitatile produsului.Pentru aceasta, probele ce provin din produse ce se pastreaza la temperatura de refrigerare sau la cele sub forma congelata, transportul se face in lazi izoterme pentru a ajunge la laborator nemodificate.
La sosirea in laborator:
* Dupa primirea probelor , se va consemna starea in care au sosit;
* Inainte de examenul bacteriologic propriu-zis, trebuie efectuat examenul
organoleptic, care de cele mai multe ori ofera noi date in directionarea
analizei bacteriologice;
Pentru examenul de laborator au fost prelevate probe ( oua de gaina, oua de bibilica ) din diverse magazine alimentare din pietele Bucurestene. Analizele au fost efectuate pe un esation de 20 de oua de gaina si 20 de oua de prepelita.
7.2. DETERMINAREA SOLUBILITATII
Determinarea solibilitatii in apa a produselor deshidratate sub forma de praf este un parametru de calitate obligatoriu. In timpul procesului tehnologic de deshidratare pot rezulta particule proteice denaturate termic, insolubile in apa. Acesta reprezinta un defect de calitate, deoarece reduce gradul de solubilitate al produsului in asamblu.
Principiul metodei
Separarea
particulelor insolubile si stabilizarea procentuala a
cantitatii acestora. Gradul de solubilitate se calculeaza prin
scaderea din
Materiale
Centrifuga, hartie de filtru cantitativa cu porozitate medie, pahar Berzelius, bagheta de sticla, etuva, exicator, balanta analitica.
Mod de lucru
Intr-un pahar Berzelius cu reper la 100 ml., se cantaresc 10 gr. produs. Se adauga in portiuni mici apa distilata calduta (40 C), omogenizand energic cu o bagheta de sticla pana se formeaza o pasta uniforma. Se continua adaugarea de apa sub agitare pana la reperul 100 ml., omogenizandu-se continuu cateva minute.
Imediat dupa incetarea omogenizarii se masoara 10 ml. intr-un tub de centrifuga (echivalent a 1 gr.) si se actioneaza centrifuga 5-10 minute la 1000 rotatii pe minut.
Se decanteaza lichidul si reziduul se reia cu 5 ml. apa distilata trecandu-se pe hartia de filtru, in prealabil uscata si tratata. Se spala tubul de centrifuga si filtrul in 3-4 reprize cu apa distilata calda, apoi filtrul se usuca 1 ora la etuva reglata la 103 C, se raceste in exicator si se cantareste la balanta analitica.
Calculul rezultatului
Greutatea rezidului uscat x100, arata procentul substantelor insolubile in apa.
Solubilitate % = 100 - substante insolubile %
Analizele fizico-chimice si microbiologice ale produselor de oua congelate si deshidratate, se executa dupa tehnicile oficializate sau unele prevazute in prezenta lucrare.
7.3. DETERMINAREA UMIDITATII
Determinarea umiditatii din produsele de ou deshidratat se face folosind metoda prin uscare la etuva.
Principiul metodei
Proba
luata in lucru se expune la o sursa de caldura la
temperatura de
Materiale
Balanta analitica cu precizie de
Mod de lucru
Este
indicat ca detreminarea sa se faca in dublu pentru fiecare proba
analizata. In cele doua fiole de cantarire cu capac si
bagheta de sticla se introduc cate
Nisipul de mare este necesar mai ales cand produsul din ou este sub forma de pasta pentru a mari suparafata de evaporare.
Dupa cantarire fiolele se introduc in etuva la 103 C, unde se mentin minim 4 ore, dupa care se scot si se introduc in exicator. Se cantareste fiecare fiola si se noteaza greutatea. Se repeta operatiile de incalzire la etuva, racire si cantarire pana la greutatea constanta (intre doua cantariri succesive nu se obtine o diferenta mai mare de 0,0005 g).
Calculul rezultatelor
Umiditatea probei se calculeaza dupa formula:
Apa % = m - m1 / m2 x 100
In care:
m = masa fiolei cu bagheta si nisip plus produsul, inainte de uscare;
m1 = masa fiolei cu bagheta si nisip plus produsul dupa uscare;
m2 = cantitatea de produs luata in analiza
Ca
rezultat se ia media aritmetica a doua determinari paralele care
nu difera intre ele cu mai mult de
7.4 . DETERMINAREA CANTITATII DE GRASIME
Detrminarea cantitatii de grasime la produsele de ou deshidratate ne ofera date suficiente de conclundente pentru decelarea substituirilor intre ele. Cantiatea de grasime minima pretinsa este de 38 % la oul integral praf, 58 % la praful de galbenus si numai urme ( maxim 0.4 % ) la albusul praf.
Cu cat cantitatea de grasime din produsul analizat este mai scazuta, fata de valoarea minima pretinsa de 58 % la galbenusul praf, cu atat proportia de praf de ou integral amestecata cu galbenusul este mult mai mare. Valorile parametrului grasime apropiate de 38 % ( limita minima pentru ou integral praf ) se aproprie de certitudinea falsificarii prin substitiure a galbenusului praf cu praf de ou integral. Lipsa grasimii din proba analizata ( eventualele urme ) atesta ca avem de aface cu albusul praf.
Determinarea grasimii din produsele de ou deshidratat se face prin metoda de extactie Soxhlet.
Principiul metodei
Grasimea din proba de cercetat este extrasa pana la epuizare cu solventi organici si dupa indepartarea solventului de extractie se cantareste si se exprima procentual.
Aparatura si reactivi
Dispozitiv de extractie Soxhlet, eter etilic anhidru si cloroform, cartuse filtrante uscate si degresate.
Mod de lucru
Se
cantaresc
Extractia dureaza 5-6 ore si trebuie in asa fel dirijata, incat sa se realizeze 10-12 sifonari pe ora.La terminarea extractiei se distila cloroformul din balon, apoi acesta se usuca la etuva 103 grade pana la masa constanta.Diferenta intre masa balonului initial si a balonului dupa evaporarea cloroformului reprezinta cantitatea de grasime din proba.
Calculul rezultatelor
Cantitatea de grasime se calculeaza dupa formula:
Grasime % =m / m1 X 100
In care :
* m = cantitatea de grasime extrasa, in g;
* m 1= cantitatea de produs luat in lucru.
7.5. EXAMENUL BACTERIOLOGIC PENTRU BACTERII DIN GENUL SALMONELLA
Din punct de vedere al frecventei, dar si al implicatiilor igionico-sanitare, toxiinfectiile alimentare produse de salmonele in majoritatea tarilor, ocupa primul loc.Acestea apar frecvent in purtatori umani si animali, temperatura fiind un factor favorabil pentru dezvoltarea si multiplicarea gremenilor.
In vederea recunoasterii genului se impune o reamintire sumara a unor elemente caracteristice.
Genul Salmonella este incadrat in familia Enterobacteriacae.Printre serotipurile intalnite in cazul toxiinfectilor alimentare la noi sunt: S.panama; S.esobony; S.erby; S.brandenburg;S.enteritidis Gartnet; S. Thomson; S.s.bovis morbificans; S.java; S.newport; S. Bredeney; S.meleagridis; S. Infantis; S. Heidelberg; S.anatum; etc.
Aceste bacterii au forma de bastonase sau cocobacili cu dimensiuni de 2-3/0,6 microni, acapsulogene, asporogene, Gram negative, mobile , cu exeptia unor mutante imobile si a unor serotipuri ( S. galiinarum/pulorum).Sunt bacterii aerobe, facultativ-anaerobe, se dezvolta bine pe medi nutritive obisnuite, cu pH in jur de 7,0 la temperatura de 37 grade.
Aceste bacterii nu se multiplica la temperaturi mai mici de 10 grade si la un pH mai mic de 4,5-5, sunt distruse rapid de dezifectantele uzuale.
Principalele caracteristici biochimice ale salmonelelor sunt:
* Frementarea glucozei cu producere de gaze;
* Producerea de hidrogen sulfurat;
* Folosirea citratului ca unica sursa de carbon;
* Nu fermenteaza lactoza si zaharoza;
* Nu produc idol si ureaza.
Principiul metodei
Dectectarea prezentei salmonelelor se face prin insamantarea probei in mediu lichid neselectiv de preambogatire, incubarea la 37 grade, apoi insamantarea in doua medii lichide selective de imbogatire, folosind cultura din mediul de preambogatire, incubarea la 37 grade si izolarea prin insamantare din cele doua medii de imbogatire pe medii selectiv solide, care dupa incubare la 37 grade sunt controlate pentru prezenta coloniilor suspecte de Salmonella si confirmate prin teste de indentificare.

Figura nr.11-Punerea in evidenta a Salmonellelor
7.6. DETERMINAREA NUMARULUI TOTAL DE GERMENI MEZOFILI ANAEROBI ( N.T.G.M.A.)
Numarul total de germeni mezofili aerobi reprezinta un indicator sanitar care ne ofera date privitoare la starea de contaminare a produsului alimentar sau obiectivului de examinat ( aerul din spatiul de lucru si spatiu de depozitare, utilaje, instrumente, suprafete de lucru, echipamente de protectie, recipiente de sticla sau din material plastic, hartie pergamentata sau folii de material plastic, conducte de la instalatia de pasteurizare etc.)
Acest parametru se refera doar la micoorganismele vii din proba de aliment ce urmeaza a fi analizata , neincluzand alti germeni decat cei aerobi, in majoritate bacterii.
Determinarea acestui parametru se bazeaza pe inglobarea unei cantitati din produsul alimentar supus controlului, intr-un mediu nutritiv adecvat turnat in placi Petri.
Dupa inoculare, din fiecare gramada de germeni sau din fiecare microrganism se va dezvolta o colonie.

Figura nr. 12-Punerea in evidenta a germenilor aerobi
7.7. DETERMINAREA SI PREZENTA BACTERIILOR SULFITO-REDUCATOARE
Clostridiile sulfito-reducatoare sunt bacilli Gram pozitivi, sporulati, strict anaerobi, care in anumite conditii de cultivare produc H2S si in majoritatea cazurilor reduce sulfitul.In aceasta categorie intra Cl.perfringens alaturi de alte specii inrudite capabile sa reduca sulfitul ( Cl.butirycum, Cl.putreacieus etc.)
Prin asemanarea morfologica cu unele specii patogene, uneori acestea pot crea confuzii in diagnostic, majoritatea speciilor intra in categoria " clostridii sulfito-reducatoare" fiind agenti importanti ai putrefactiei.
Aparatura si materiale:
* balanta de precizie sau balanta cu monoplatan si cadran;
* termostat reglabil la 35 grade;
* bai de apa termoreglabila, reglata la 50 grade;
* mojare cu pistil sterile sau omogenizator electric tip " Stomacher"
* foarfece, pense, baghete de sticla sterile;
* placi Petri sterile cu diametrul de
* eprubete sterile cu lumenul de 0,8-
eprubete cu partea inferioara ovala pe sectiune ( Miller-Prickett);
* bucati de mucava ( carton presat hidrofil dretunhiulare cu laturile de 5,5 X
de aceleasi dimensiuni imbibate in carbonat de potasiu solutie 6 %.Se
pastreaza la rece in recipiente de sticla inchise la culoare si cu dop rodat;
* anaerostat portativ sau etuva anaerostat;
Medii de cultura:
a.agar cu sulfit de sodiu, polimixina B si neomicina;
Mediu de baza:
Triptona .15 g
Extract de drojdie .10 g
Galbenus .3 g
Sulfit de sodiu 0,05 g
Sulfat feros ..0,02 g
Agar .15 g
Apa distilata.1000 g
p H = 7
Mediul, dupa dizolvarea substantelor prin fierbere se repartizeaza in baloane de 100 ml de mediu, apoi se sterilizeaza. In momentul folosirii la 100 ml de mediu de baza se adauga 2 ml polmixina B sulfat, solutie 0,1 % si un mililitru neomicina solutie ,0,5 %.
Se poate turna in placi care se vor incuba in anaerbioza.Bacteriile sulfito-reducatoare dezvolta culori negre, ceea ce se poate observa si in figura urmatoare:

Figura nr. 13 - Determinarea sulfito-reducatorilor in placi Petri (metoda directa)
Mod de lucru:
Prezenta si numarul de colostridii sulfito-reducatoare se poate determina atat in placi cat si in eprubete.
* Determinarea in paci Petri cu incubarea in anaerostat, sau prin cultivare in placi in care anaerobioza se realizeaza cu amestec de pirogol si carbonat de potasiu.
Confirmarea se face prin :
* examenul bacterioscopic ( col. Gram ), urmarindu-se aspectul morphologic din cateva colonii;
* producerea de catalaza.
Daca bacilii sunt Gram pozitivi iar coloniile cercetate sunt catalazo- negative
Se considera confirmare pentru acesti germeni.
In figura urmatoare este redata modul de insamantare cu ansa din continutul integral.

Figura nr.14 - Insamantare cu ansa din continutul integral

Figura nr.15 - Insamantare cu ansa de pe coaja oului
CAPITOLUL VIII
REZULTATE SI DISCUTI
Probele prelevate si prelucrate dupa metodele descrise in capitolele precedente sunt analizate in concordanta cu metodele recunoscute stiintific, stabilite de legislatia comunitara sau alte standarde internationale preluate de legislatia nationala.
S-au analizat 2 seturi de probe. Rezultatele obtinute sunt prezentate in tabelul de mai jos.
|
Setul de probe nr. 1 |
Setul de probe nr. 2 |
|
Albus - 7,9 |
Albus - 7,8 |
|
Galbenus - 5,9 |
Galbenus - 6,0 |
Tabel nr. 8- Determinarea pH-ului cu hartie indicator.
Din rezultatele obtinute se observa ca, in cele doua seturi de probe, oua de gaina si oua de bibilica se incadreaza in limitele de pH stabilite in legislatia in vigoare pentru ouale proaspete.
La analiza s-a constatat o variatie a pH-ului de la 6 la 7, ceea ce conduce la un rezultat necorespunzator al starii de prospetime a oualor pentru consum.
8.1. DETERMINAREA AZOTULUI USOR HIDROLIZABIL
Determinarile s-au efectuat pe oua proaspete si praful de ou. Continutul de 29% mg amoniac pentru ou indica un ou proaspat. Pentru praful de ou continutul in amoniac este deasemenea corespunzator (30 mg% amoniac).Valorile de mai sus se incadreaza in limitele prevazute de normele sanitar veterinare in vigoare.
|
Caracteristici |
Oul crud |
Praful de ou |
Metode de analiza |
|
Azot usor hidrolizabil NH3 /100g |
STAS 9065/ 7 - 74 |
||
|
pH |
- 6,2 |
- 6,2 |
STAS 9065/ 8 - 74 |
|
Reactia pentru hidrogen sulfurat |
Negativa |
Negativa |
STAS 9065/11 - 75 |
|
Reactia Kreis |
Negativa |
Negativa |
STAS 9065/10 - 75 |
|
Reactia pentru identificarea amoniacului |
Negativa |
Negativa |
STAS 9065/ 7 - 74 |
Determinari fizico - chimice pe ou ca atare, prevazute de legislatia in vigoare.
Caracteristici si metode de analiza pentru oul de gaina si praful de ou
Tabel nr: 10
8.2. DETERMINAREA HIDROGENULUI SULFURAT
O alta metoda de determinare a prospetimii oului o reprezinta si reactia probei in prezenta acetatului de plumb. Pentru ouale proaspete reactia este pozitiva avand in vedere ca dupa 15 minute, hirtia de filtru imbibata in acetat de plumb a ramas alba. Rezultatul analizei se incadreaza in limitele standardizate.
8.2.1. EXAMENUL ORGANOLEPTIC
Rezultatele examenului organoleptic se incadreaza in limitele proprietatilor organoleptice stabilite de Ordinul 494/859/138/24.10.2002
Rezultat: ouale corespund conditiilor de admisibilitate pentru consum.
Verificarea proprietatilor organoleptice se realizeaza conform STAS 7586-75.
8.2.2. ANALIZA MICROBIOLOGICA A COJII DE OU
La
capatul marit al oului, cu ajutorul unui bisturiu steril, se face un
orificiu de 3-
- Numar total de bacterii (NTG);
- Drojdii si mucegaiuri;
- Bacterii din genul Proteus, Salmonella (facultative);
- Bacterii coliforme.
Figura nr.16 - Evaluarea microbiozei dezvoltate dupa incubare

Figura nr. 17 - Evaluarea microbiozei dezvoltate dupa incubare
(placi Petri cu medii solide)

Figura nr. 18 - Evaluarea microbiozei dezvoltate dupa incubare
(galerii de identificare Rida-Count)
8.2.3. REZULTATE OBTINUTE IN URMA ANALIZELOR DE LABORATOR
Oul este
unul dintre cele mai hranitoare alimente avand aproximativ
Oul este o sursa importanta de fosfor lecitinic, fier bine asimilabil, calciu precum si numeroase vitamine.Grasimile din ou , valoroase din punct de vedere biologic, asociate cu lectina si cefalina, constituie tonifianti aprecianti pentru activitatea nervoasa superioara.
Continutul bogat in colesterol ( pana la 0,8 % in oul de gaina si 1,6 % in oul de rata) limiteaza consumul oualor in ratia diurna la 1 ou pentru copii si adolescenti, 0,5-1 ou pentru adulti si 2 oua/saptamana pentru varstnici.
Cunoscand
continutul in substante protidice, lipidice si glucidice, precum
si factorii de convietuire a acestora in echivalentul calorii,
valoarea nutritiva, sub raport energetic, exprimata in calorii la
Grafic nr. 4 - Evaluarea valorii energetice a oului
. Oul
face parte din categoria alimentelor cu cel mai mare continut de
colesterol, apreciat la 2g pentru
Din punct de vedere al starii de prospetime al probelor analizate s-au observat ca toti parametrii analizati au fost cuprinsi intre limitele prezazute de standardele in vigoare
Din punct de vedere chimic, colesterolul este un steroid cu 27 atomi de carbon in molecula. In stare pura el se prezinta ca substanta solida de culoare alba, insolubila in apa.

Colesterolul
In organism el are o distributie universala, deoarece intra in structura tuturor membranelor celulare. De asemenea, el este percursorul celorlanti compusi steroidici din organism. El indeplineste numeroase functii de importanta vitala, cum ar fi:
* participa la sinteza lipoproteinelor celulare si a lipoproteinelor
solubile din plasma;
* este un component de baza al tesutului nervos, cu rol esential in
mielinizare;
* participa la activitatea metabolica a ficatului;
* constituie materia prima pentru sinteza acizilor biliari;
* este precursorul vitaminei D3 ( Calciferolul ).
Provenienta colesterolului in organismul omului isi are originea in sursa alimentara si in sinteza endogena care se realizeaza la nivelul ficatului.
Sinteza hepatica este riguros reglata hormonal, pentru a se obtine doar atat cat este necesar trebuintelor metabolice.Cand aportul alimentar depaseste necesarul metabolic, excesul se elimina prin excretie, fie ca atare, fie sub forma de acizi biliari.Principala cale de eliminare este cea biliara si in mod secundar mucoasa intestinala.In unele tulburari metabolice, o parte din exces se poate depozita in tesuturi si umori generand stari patologice de tip ateromatozei.Depozitele formate sunt alcatuite din colesterol ca atare, deoarece in stare pura el nu este solubil in mediu apos.
Toxiinfectiile alimentare produse de Salmonelle, constituie alt risc.
Statisticile internationale situeaza toxiinfectiile alimentare produse de salmonelle pe primul loc, iar principala sursa o constituie carnea de pasare, si in mod special ouale.
Oul, in special cel de la palmipede, este considerat potential contaminat cu salmonelle.
Salmonella constituie genul cel mai mare din familia Enterobacteriaceae, care cuprinde peste 1500 de serotipuri ce contamineaza in mod frecvent alimentele, in special cele de origine animala.Toate serotipurile cunoscute sunt considerate potential patogene pentru om.Adesea, salmonelele fac parte din grupa enterobacteriaceelor ce populeaza tractusul intestinal.
Contaminarea oualor poate fi intravitala si se refera la pasarile care au trecut prin boala, dar care raman purtatoare pe intreaga lor viata economica, precum si cele sanatoase dar purtatoare.Contaminarea intravitala se poate efectua pe oricare din verigile lantului de formare a oului, incepand cu ovarul si terminand cu momentul expulzarii.
La gaini insa comtaminarea extravitala este cea mai frecventa.Ea se realizeaza prin contactul oului cu excrementele din cuibare sau de pe celelalte suprafete, nesatisfacator igenizate, la randul lor contaminate.De asemenea, oamenii purtatori de salmonelle, care vin in contact cu ouale, sau care participa la prepararea lor culinara, contribuie la instalarea acestei nereguli.Verigile lantului in circuitul salmonelelor in natura sunt extrem de numeroase.Printre acestea un loc particular il ocupa furajele si mai ales, apa in unitatile de crestere a gainilor outoare.In apa din adaposturi salmonelele se inmultesc foarte repede si pe aceasta cale pasarile ingera un numar foarte mare de germeni.Ajunse in intestin ele se inmultesc in continuare si invadeaza intregul organism, inclusiv ovarul, chiar daca nu declanseaza forme evidente de boala.
Contaminarea extravitala a oului este favorizata de unele particularitati.In momentul expulzarii coaja este acoperita cu o pelicula umeda de mucus, care capteaza si fixeaza impuritatile cu care vine in contact, inclusiv cele din praful atmosferic.De pe coaja, salmonelele trec usor in galbenus si albus unde se inmultesc in continuare daca oul este pastrat la temperaturi mai mari de 15 grade.
Totusi, salmonelele prezinta avantajul ca sunt foarte sensibile la factorii vitregi de mediu.Astfel, temperatura de 60 grade le omoara in cateva minute.De asemenea, ele nu se inmultesc la temperaturi mai scazute de 10 grade, iar prin deschidratare ( uscare ) substratului in care sunt incorporate si sub actiunea radiatiilor solare, se distrug foarte repede.
In alimente insa, ele persista mult timp, in conditii obisnuite de pastrare.
CAPITOLUL IX
CONCLUZII GENERALE SI RECOMANDARI
9.1. CONCLUZII GENERALE
In urma controlului igienico - sanitar efectuat in Laboratorul de Control al Alimentelor din cadrul Facultatii de Medicina Veterinara Bucuresti, rezultatele examenelor privind loturile de oua din care au fost recoltate probe, au demonstrat ca sunt intruniti toti parametrici organoleptici si chimici impusi de normele standard in vigoare .
Analiza probelor de oua
In urma expertizarii unui numar de 20 oua din reteaua comerciala a Municipiului Bucuresti, din care : 8 oua de gaina, 6 de bibilica, 6 de rata, sau depistat urmatoarele concluzii:
Examenul organoleptic a demonstrat ca toate probele de oua corespund principalelor indicatori organoleptici. Din punct de vedere starii de prospetime al probelor analizate s-au observat ca toti parametrii analizati au fost cuprinsi intre limitele prezazute de standardele in vigoare.
In urma studiilor efectuate, s-a constatat o buna cunoastere si intelegere a problemelor privind comercializarea produselor de origine animala, in reteaua comerciala a Municipiului Bucuresti . Totodata, trebuie sa mentionam si oportunitatile oferite de legislatia in vigoare care, impune constrageri dar ofera si facilitati in sprijinul celor implicati in comercializarea oualor si produselor din oua. Unitatile de desfacere indeplinesc conditiile impuse de actele normative in vigoare:
. Spatiile de prezentare si desfacere sunt corespunzatoare pentru comercializarea produselor din oua ;
. Aprovizionarea punctelor de desfacere se face ritmic in functie de solicitarile fiecarui punct de comercializare;
. Ouale comercializate in punctele de desfacere provin din unitati autorizate si indeplinesc cerintele prevazute de reglementarile sanitar-veterinar in vigoare ;
. Ouale proaspete sunt depozitate in conformitate cu prevederile normelor sanitar-veterinare in depozite frigorifice, autorizate de autoritatea veterinara competenta ;
. Personalul, spatiile si utilajele din unitatile de comercializare prezinta un grad inalt de igiena. Deasemenea, personalul care lucreaza in spatii si zone in care se transporta, manipuleaza ouale, poarta in special mijloace de protectie totala a parului, haine de lucru in culori deschise, curate si usor de curatat potrivit normelor igienico-sanitare in vigoare.
. Examinarea oualor se efectueaza in conformitate cu metodele recunoscute din punct de vedere stiintific, in special metodele care sunt definite in legislatia comunitara sau in alte standarde internationale.
Cercetarile efectuate evidentiaza in general, ca igiena spatiilor de comercializare a oualor asigura conditii bune de salubritate pentru produsele comercializate. Exista insa si exceptii, in cazul unor probe recoltate de pe unele suprafete, la care s-au constatat depasiri ale NTG si prezenta bacteriilor coliforme. Ca urmare, in prezent se acorda o mai mare atentie efectuarii operatiilor de spalare si dezinfectare.
9.2. RECOMANDARI
In scopul unei mai bune intelegeri a problemelor privind comercializarea oualor (cu toate aspectele adiacente - privind actiuni corective ce se impun a fi intreprinse de catre producatori, distribuitori, comercianti - pentru limitarea consecintelor provocate de produsele periculoase, inclusiv retragerea din circuitul de distributie si returnarea de la consumatori )se recomanda :
Realizarea unei protectii a consumatorilor in Romania asemanatoare cu cea existenta in statele membre ale Uniunii Europene, incluzand securitatea, interesele economice, informarea si educarea consumatorilor, pentru dezvoltarea unui rol activ a consumatorilor in realizarea unor produse si servicii de calitate in domeniul comercializarii oualor si produselor derivate din acestea.
Elaborarea de acte normative sau de modificari si completari ale legislatiei existente, in functie de aparitia unor noi reglementari europene, de modificari si completari ale acquisului comunitar ;
Elaborarea de documente referitoare la implementarea legii privind securitatea generala a produselor si problemele specifice de securitate ;
Dezvoltarea unei politici de protectie a consumatorilor, riguroase si bine organizate de prevenire. In plus, intarirea parteneriatului cu societatea civila, in general, si cu cercurile de afaceri, in special, va conduce la o crestere calitativa a produselor si seviciilor;
Elaborarea de strategii pentru supravegherea pietei produselor de origine animala, serviciilor si protectia consumatorilor ;
Derularea de activitati de consultanta pentru persoane juridice, in scopul unei mai bune intelegeri a problemelor privind protectia consumatorilor si al stabilirii unui parteneriat cu societatea civila si cu reprezentantii cercurilor de afaceri ;
Stabilirea de actiuni corective ce trebuie intreprinse de catre producatori, distribuitori si in cadrul punctelor de comercializare, pentru limitarea consecintelor provocate de produsele periculoase, inclusiv retragerea din circuitul de distributie si returnarea de la consumatori;
Schimbul de informatii pentru identificarea produselor cu risc, descrierea completa si corecta a riscului, cantitatea de produse aflate in reteaua de distributie, mijloacele de realizare a actiunii corective ;
Modalitatile de informare a consumatorilor privind riscurile produselor aflate in reteaua de comercializare sau la consumatori.
Cresterea capacitatii de analiza si testare privind securitatea si/sau conformitatea produselor, inclusiv depistarea produselor contrafacute, prin dotarea laboratoarelor;
Cresterea numarului de personal, in scopul imbunatatirii capacitatii de supraveghere a pietei;
Aplicarea efectiva a legislatiei armonizate in domeniul protectiei consumatorilor si intarirea cooperarii, la nivel national si european, prin preluarea celor mai bune practici in domeniul supravegherii pietei, reprezinta elemente esentiale pentru a se asigura accesul consumatorilor la produse si servicii mai sigure , o alegere mai buna, informatii mai complete despre produse si servicii, realizandu-se astfel un nivel de protectie a consumatorilor asemanator celui existent in statele membre ale Uniunii Europene.
Lucrarea de fata atesta faptul ca in urma analizelor care se fac in cadrul Laboratorului de Control al Alimentelor asupra oualor, se pot depista alimentele care nu corespund igienic si calitativ normelor in vigoare, luandu-se in acest sens masuri pentru imbunatatirea calitatilor igienice.
Prin neasigurarea conditiilor optime de pastrare oricand se poate denatura oul, sau chiar se pot contamina cu o serie de bacterii conditionat patogene sau nepatogene, ce pot sta la baza unor episoade grave de toxiinfectii alimentare.
Omul are la indemana mijloace eficiente pentru eliminarea sigura a riscului de imbolnavire prin consumul de oua, cu conditia ca acestea sa fie respectate:
* Cosiderand coaja oualor potential contaminata cu salmonele, este necesar ca ele sa nu se pastreze in acelasi spatiu cu produsele alimentare direct consumabile.De asemenea, dupa manipularea lor, oamenii trebuie sa se spele bine pe maini cu apa si sapun, inainte de a lua contact cu alte alimente.
* Persoanele care manipuleaza ouale destinate consumului public, inclusiv cele care participa la pregatirea preparatelor din oua, trebuie sa efectueze periodic controlul medical pentru a avea garantia ca nu sunt purtatoare de salmonele.
* Intruncat salmonelele nu se pot inmulti la temperatura mai mica de 10 grade, este bine ca ouale sa se pastreze la temperatura de 0-10 grade, de preferinta la frigider.
* Pentru consumul oului ca atare, trebuie sa fie bine fiert pana la intarirea prin coagulare atat al albusului cat si a galbenusului.Intruncat galbenusul are un continut mare de grasime, care limiteaza penetratia termica si protejeaza salmonelele eventual prezente, este necesar ca aceasi regula sa se respecte si la prepararea ochiurilor ( prajirea pana la intarirea galbenusului ).
* La spargerea oului trebuie procedat cu grij, in asa fel incat continutul sa nu vina in contact cu suprafata externa a cojii si nici sa nu cada fragmente de coaja in acesta.
* Cele mai mari riscuri de toxiinfectii alimentare cu salmonele se inregistreaza in urma consumului de preparate obisnuite din oua crude ( care nu au fost supuse tratamentului termic ), cum ar fi maionezele sau alte preparate asemanatoare, ori spumele si alte preparate din albusul crud de ou.Este necesar sa se limiteze consumul acestor preparate, iar in cazul maionezelor sa fie preparate din galbenusul fiert.
* In toate cazurile, preparatele din oua destinate consumului public trebuie obtinute in conditii severe de igiena, sa fi pastrate la temperaturi scazute si o perioada scurta de timp.
* Produsele din oua destinate consumului public trebuie sa fie analizate periodic prin examen microbiologic de laborator si ori de cate ori apar situatii de necesitate.
Conservarea indelungata a continutului oualor se realizeaza prin doua procedee industriale: congelarea si dehidratarea.Prin aceasta procedura se asigura comertul cu tarile indepartate si se creaza rezerve de hrana pentru o perioada indelungata de timp.
Principala conditie a procedeelor aplicate, o constituie distrugerea germenilor patogeni, in special salmonelele, fara afectarea calitatii oului proaspat.
Procedeul corect aplicat, trebuie sa asigure urmatoarele conditii microbiologice pentru ambele categori de produse:
- Salmonella, absent /
- Stafilococu auriu c.p. ,
absent /
- Bacterii coliforme , absent
/
* Aplicarea efectiva a legislatiei armonizate in domeniul protectiei consumatorilor si intarirea cooperarii, la nivel national si european, prin preluarea celor mai bune practici in domeniul supravegherii pietei, reprezinta elementele esentiale pentru a se asigura accesul consumatorilor la produse si servicii mai sigure si mai sanatoase, o alegere mai buna, informatii mai complecte despre produse si servicii, realizandu-se astfel un nivel de protectie a consumatorilor.
Desi probele prelevate si analizate s-au incadrat in parametrii igienici, prin neasigurarea conditiilor optime de pastrare oricand se poate denatura produsul sau chiar se pot contamina cu o serie de bacterii conditionat patogene sau ce pot sta la baza unor episoade grave de toxiinfectii alimentare.
Rezultatele analizelor de laborator efectuate pe probe prelevate din materia prima si din diferite tipuri si categorii de produse finite vor fi interpretate statistic in vederea implementarii unui sistem de management al riscurilor (HACCP) si apoi in cadrul unui sistem integrat de management al calitatii totale conform referentialului SR EN ISO 22.000 : 2005, in scopul respectarii prevederilor legislative conform Regulamentului European 882 / 2004 si a altor normative referitoare la implementarea sistemelor de management al calitatii si sigurantei alimentare.
BIBLIOGRAFIE SELECTIVA
Banu, C.- Biotehnologii in industria alimentara, Editura Tehnica, Bucuresti, 2000.
Barzoi, D- Microbiologia produselor alimentare de origine animala, Editura Ceres, Bucuresti, 1985.
Barzoi, D; Meica, S.; Negut, M. - Toxiinfectiile alimentare, Editura Diacon Ceres, Bucuresti, 1985.
Beate & Leopold Peitz - Cresterea gainilor, Editura M.A.S.T., Bucuresti, 2004
Boboc Viorica, Cioceanu Marian - Ghid tehnic pentru cresterea prepelitelor, Editura Atar, Bucuresti, 2005.
Constantin, N. - Tratat de medicia veterinara , vol I, Editura Tehnica, Bucuresti, 2001.
Crivineanu, V,; Rampeanu, M. - Toxicologie sanitara -veterinara,Editura Coral Sanivet, Bucuresti, 1996.
Doyle, M.- Food Microbiology, Editura M. Dekker,New York, U.S.A., 1997.
Gontea, I.-Alimentatia rationala a omului, Editura Didactica si Pedagogica, Bucuresti, 1971.
Gontea, I.- Bazele alimentatiei, Editura Medicala, Bucuresti, 1963
Horst Von Luttitz - Crescatoria de rate si gaste, Editura M.A.S.T., Bucuresti, 2003.
Ienistea, C.- Microbiologia alimentara, Editua Medicala, Bucuresti, 1958.
Jantea, F., - Microorganisme din alimente, in revista Igiena in industria alimentara, Bucuresti, 1976.
Laurentiu Tudor - Controlul sanitar veterinar si tehnologia produselor de origine animala, Editura Printech, Bucuresti, 2005.
Moga, A., Haragus, S., - Ateroscleroza, Editura Academiei, Dima, D.; Pamfilie, R.; (2001); Marfurile alimentare in comertul international. Editura Economica, Bucuresti.
Nicolae Cornila - Morfologia microscopica a animalelor domestice vol. I , Editura All, Bucuresti, 2000.
Nicolae Dojana -Compediu de fiziologie animala si etologie, Editura Printech, Bucuresti, 2004.
Papa, G.; Stanescu, V. - Tehnologia si expertiza sanitar-veterinara, Editura Didactica si Pedagogica, Bucuresti, 1968.
Papuc Camelia, Mihai Serban, Aneta Pop - Metode analitice in biochimia veterinara, Editura Printech, Bucuresti, 2004.
Popa Gavrila - Lucrari practice de expertiza sanitar- veterinara, Editura Didactica si Pedagogica , Bucuresti, 1964.
Popa, G., Popescu, N.,-Ghid pentru controlul alimentelor de origine animala , Editura Ceres, Bucuresti, 1973.
Popa, G.-Toxicologia produselor alimentare si bauturilor, Editura Academiei, Bucuresti, 1986.
Popescu, Aurora -Biochimia medicala, Editura Medicala, Bucuresti, 1980.
Popescu, N., Meica, S.,- Notiuni si elemente practice de chimie analitica sanitar veterinara, Editura Diacon Coresi, Bucuresti, 1993.
Popescu, N., Meica, S.,-Bazele controlului sanitar veterinar al produselor de origine animala, Editura Diacon Coresi, Bucuresti, 1995.
Popescu, N., Popa, G., Stanescu, V.,- Determinari fizico-chimice de laborator pentru controlul produselor de origine animala, Editura Ceres, Bucuresti, 1986.
Serban, M., Tamas, V., Cotrut, M., - Biochimie medicala veterinara, Editura Didactica si Pedagogica, Bucuresti, 1982.
Suteanu, E.; Danielescu, N.,; Popescu, O.; Trif, A. - Toxicologie si toxicoze, Editura Didactica si Pedagogica, Bucuresti, 1995.
Tudor Laurentiu, Petcu E., Stancu,I.-Masuri privind salubritatea produselor alimentare de origine animala, Editura Coral Sanivet, Bucuresti 2001.
Popescu,D.V.; (2001) - Alimentatie. Editura A.S.E.,Bucuresti
Popescu,D.V.; (2003) -Impactul politicelor alimentare si nutritionale asupra comertului international cu bunuri alimentare.Teza de doctorat,Editura A.S.E.
Bucuresti
Stanescu,D.; (1999) - Alimentatie-catering Editura Oscar Print.Bucuresti
Stanescu,D.; (1998) -Igiena si controlul alementelor.Editura "Fundatiei "Romania de maine".Bucuresti.
Arduser, Lora; Douglas, R.B.; (2005) - HACCP & Sanitation in Restaurants and Food Service Operations: A Practical Guide Based on the FDA Food Code with CDROM. Publisher Atlantic Publishing Company (FL), Har/Cdr edition, ISBN-10: 0910627355.
Banu, C. (coord.); (2002) Manualul inginerului de industrie alimentara. Vol. I si II, Editura Tehnica, Bucuresti.
Barzoi, D.; Meica, S.; Negrut, M.; (1999)- Toxiinfectiile alimentare. Editura Diacon Coresi, Bucuresti.
Mincu, I.; (1993); Impactul om - alimentatie. Editura Medicala, Bucuresti
Ciurea, S.;Dragulescu, N.; (1995) - Managementul calitatii totale-standardele ISO9004 comentate".Editura Printech,Bucuresti
Fondu, M.; (2001); - Alimentele noi si cadrul legislativ.Buletin Informativ pentru industria alimentara, Bucuresti.
Olaru, M.; Pamfilie, R. si col.; (1999)-Fundamentele stiintei marfurilor.Editura Eficient,Bucuresti
Patriche, D.; Pistol, G.; (1998)-Protectia consumatorilor.Editura A.S.E.,Bucuresti.
Olinescu, M. si col.; (2000);- Totul despre o alimentatie sanatoasa.Editura Niculescu,Bucuresti
|
Politica de confidentialitate | Termeni si conditii de utilizare |
Vizualizari: 10786
Importanta: ![]()
Termeni si conditii de utilizare | Contact
© SCRIGROUP 2026 . All rights reserved